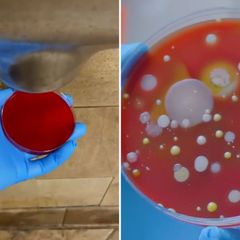

| |
Police News Review at 8 p.m. EST Daily
Current Police News: https://www.inoreader.com/stream/user/1006407045/tag/Police%20News%20Review/view/html?cs=m&sb=y
The News And Times - https://thenewsandtimes.blogspot.com/
Current Selected Articles: https://www.inoreader.com/stream/user/1006407045/tag/user-favorites/view/html
All Current Articles: https://www.inoreader.com/stream/user/1006407045/tag/all-articles/view/html |
|
|
|
 | Inside Jennifer Flavin's divorce filing that 'blindsided' hubby Sylvester Stallone |
| Sylvester Stallone was said to be "blindsided" by wife Jennifer Flavin's Aug. 19 divorce filing, as friends... |
 NY Post: NYPD Blotter NY Post: NYPD Blotter | 5m | |
|
|
|
 | Sheriffs rescue stranded family from steep California canyon after three days |
| Five California agencies came to the rescue of a family that had been stranded in the Tahoe National... |
 NY Post: NYPD Blotter NY Post: NYPD Blotter | 5m | |
|
|
|
 | Tyler Stanaland didn't want wife Brittany Snow on 'Selling the OC' |
| "As we as this journey started, I kind of wanted to keep certain parts of my life private," the new Netflix... |
 NY Post: NYPD Blotter NY Post: NYPD Blotter | 5m | |
|
|
|
 | Carl Paladino concedes House primary loss in blow to Elise Stefanik |
| "It is time to move onto the next chapter of my life," said Paladino. "I am forever grateful for this... |
 NY Post: NYPD Blotter NY Post: NYPD Blotter | 5m | |
|
|
|
 | Jenny McCarthy: My heart breaks for Playmates abused by Hugh Hefner |
| The former Playmate of the Year discussed why she declined the chance to host "Secrets of Playboy" —... |
 NY Post: NYPD Blotter NY Post: NYPD Blotter | 5m | |
|
|
|
 | Notorious vegan activist Tash Peterson strips down in Louis Vuitton store — again |
| Notorious vegan activist Tash Peterson has celebrated the anniversary of her "most powerful protest"... |
 NY Post: NYPD Blotter NY Post: NYPD Blotter | 5m | |
|
|
|
 | Video shows migrants attacking, taunting Border Patrol agents |
| "Without any support by this administration and thanks to their open border policies, disrespect and... |
 NY Post: NYPD Blotter NY Post: NYPD Blotter | 5m | |
|
|
|
 | Vivica A. Fox: Jada Pinkett Smith has ghosted me since Will's Oscars slap |
| "I think they're just really going through a season of healing right now," Fox said. |
 NY Post: NYPD Blotter NY Post: NYPD Blotter | 5m | |
|
|
|
 | Sylvester Stallone's children: Meet his five sons and daughters |
| Stallon fathered five kids, sharing three daughters with estranged wife, Jennifer Flavia. He also welcomed... |
 NY Post: NYPD Blotter NY Post: NYPD Blotter | 5m | |
|
|
|
 | Jury awards Vanessa Bryant $16M in lawsuit over Kobe crash photos |
| A federal jury found Wednesday that Los Angeles County must pay Kobe Bryant's widow $16 million over... |
 NY Post: NYPD Blotter NY Post: NYPD Blotter | 5m | |
|
|
|
 | Dr. Fauci's war on science, Garland's 'accidental launch' and other commentary |
| Anthony Fauci did his best to debunk the anti-COVID-hawkism Great Barrington Declaration just "four days... |
 NY Post: NYPD Blotter NY Post: NYPD Blotter | 5m | |
|
|
|
 | Ex-NYC Mayor de Blasio to teach at Harvard after flunking congressional campaign |
| Former Mayor Bill De Blasio, a Red Sox fan, is sure to be right at home at Harvard's ritzy Cambridge,... |
 NY Post: NYPD Blotter NY Post: NYPD Blotter | 5m | |
|
|
|
 | Harvey Weinstein says he's 'hopeful' after NY high court grants right to appeal |
| New York's highest court has agreed to hear Harvey Weinstein's appeal of his 2020 rape and sexual assault... |
 NY Post: NYPD Blotter NY Post: NYPD Blotter | 5m | |
|
|
|
 | One-third of New Yorkers are less satisfied with their lives: poll |
| Only 27% of New Yorkers were more content with their lives than they were a year ago, down from 44% in... |
 NY Post: NYPD Blotter NY Post: NYPD Blotter | 5m | |
|
|
|
 | August heat can't slow down explosive Saquon Barkley |
| Running back Saquon Barkley was particularly explosive on Wednesday, taking multiple runs to the house. |
 NY Post: NYPD Blotter NY Post: NYPD Blotter | 5m | |
|
|
|
 | Wait goes on for NYC housing vouchers despite 'immediate' fix pledge |
| "The City must make good on their promise and amend its rules to enable eligible households immediate... |
 NY Post: NYPD Blotter NY Post: NYPD Blotter | 5m | |
|
|
|
 | Aubrey Plaza dishes on Danny DeVito's 'deadbeat dad' Satan in 'Little Demon' |
| FXX's "Little Demon" stars Aubrey Plaza as single mom Laura, Lucy DeVito as her teen daughter Chrissy... |
 NY Post: NYPD Blotter NY Post: NYPD Blotter | 5m | |
|
|
|
 | Paul Pelosi's DUI-wrecked Porsche up for auction |
| The luxury Porsche Paul Pelosi drunkenly crashed in California in May could be yours. |
 NY Post: NYPD Blotter NY Post: NYPD Blotter | 5m | |
|
|
|
 | Sauce Gardner making case to start, while O-Line struggles at Jets camp |
| Observations from Jets training camp on Wednesday. |
 NY Post: NYPD Blotter NY Post: NYPD Blotter | 5m | |
|
|
|
 | Boston Children's Hospital's transgender insanity reveals how unhinged elites make... |
| Data show that "socially transitioned" children are far more likely to go on to medical interventions.... |
 NY Post: NYPD Blotter NY Post: NYPD Blotter | 5m | |
|
|
|
| Birmingham Police issue Critical Missing Person alert for 61-year-old woman - WBRC |
| Birmingham Police issue Critical Missing Person alert for 61-year-old woman WBRC |
 "police" - Google News "police" - Google News | 18m | |
|
|
|
| Checotah Police Capture Suspect Related To PCSO Deputy Death, School Lockdowns -... |
| Checotah Police Capture Suspect Related To PCSO Deputy Death, School Lockdowns News On 6 |
 "police" - Google News "police" - Google News | 18m | |
|
|
|
| Police: 15-year-old identified as suspect in two Springfield arson fires - Western... |
| Police: 15-year-old identified as suspect in two Springfield arson fires Western Massachusetts News |
 "police" - Google News "police" - Google News | 18m | |
|
|
|
| Mt. Juliet Police officer decommissioned over allegations of 'possible criminal wrongdoing'... |
| Mt. Juliet Police officer decommissioned over allegations of 'possible criminal wrongdoing' WSMV 4 |
 "police" - Google News "police" - Google News | 18m | |
|
|
|
| FACT SHEET: President Biden's Safer America Plan - The White House |
| FACT SHEET: President Biden's Safer America Plan The White House |
 "police" - Google News "police" - Google News | 18m | |
|
|
|
| Uvalde school chief defends actions ahead of possible firing - PBS NewsHour |
| Uvalde school chief defends actions ahead of possible firing PBS NewsHour |
 "Robb Elementary Uvalde" - Google News "Robb Elementary Uvalde" - Google News | 28m | |
|
|
|
 | CA trans predator walks free after messaging who he thought was 9-year-old girl about... |
| Editor note: This article was originally published by our friends at Red Voice Media and was written... |
 Law Enforcement Today Law Enforcement Today | 34m | |
|
|
|
| NYPD seeking help identifying man brought to Brooklyn hospital - 1010 WINS |
| NYPD seeking help identifying man brought to Brooklyn hospital 1010 WINS |
 "NYPD" - Google News "NYPD" - Google News | 41m | |
|
|
|
| NYPD Cracking Down on Ghost Guns With New Regulations - NBC New York |
| NYPD Cracking Down on Ghost Guns With New Regulations NBC New York |
 "NYPD" - Google News "NYPD" - Google News | 41m | |
|
|
|
| Huntsville Police sends travel suggestions to drivers in Morris school zones - WAFF |
| Huntsville Police sends travel suggestions to drivers in Morris school zones WAFF |
 "police" - Google News "police" - Google News | 48m | |
|
|
|
| Business near Sumter Mall receives threat, police advise avoiding area - WIS News... |
| Business near Sumter Mall receives threat, police advise avoiding area WIS News 10 |
 "police" - Google News "police" - Google News | 48m | |
|
|
|
| Sit. Stay. Fido? Puppy Stuck in Recliner Has to Be Rescued By Police - NBC10 Boston |
| Sit. Stay. Fido? Puppy Stuck in Recliner Has to Be Rescued By Police NBC10 Boston |
 "police" - Google News "police" - Google News | 48m | |
|
|
|
| Have you seen Amirah? Houston police searching for missing 10-year-old girl last... |
| Have you seen Amirah? Houston police searching for missing 10-year-old girl last seen this morning in... |
 "police" - Google News "police" - Google News | 48m | |
|
|
|
| Alabama man accused of resisting police in Jan. 6 riots allegedly told officers 'you're... |
| Alabama man accused of resisting police in Jan. 6 riots allegedly told officers 'you're gonna lose' AL.com |
 "police" - Google News "police" - Google News | 48m | |
|
|
|
| Man arrested for stealing from Wilkinsburg finance department, police say - WPXI... |
| Man arrested for stealing from Wilkinsburg finance department, police say WPXI Pittsburgh |
 "police" - Google News "police" - Google News | 48m | |
|
|
|
| Warwick police search for two individuals accused of stealing from a tow yard - Turn... |
| Warwick police search for two individuals accused of stealing from a tow yard Turn to 10 |
 "police" - Google News "police" - Google News | 48m | |
|
|
|
| POLICE: Trucker was falsely accused of attempting to grab girl walking near high... |
| POLICE: Trucker was falsely accused of attempting to grab girl walking near high school CDLLife |
 "police" - Google News "police" - Google News | 48m | |
|
|
|
| Demings Will Tout Police Career in Bid to Flip Florida Senate Seat, Oust Rubio -... |
| Demings Will Tout Police Career in Bid to Flip Florida Senate Seat, Oust Rubio Bloomberg |
 "police" - Google News "police" - Google News | 48m | |
|
|
|
| KDH Police seek information on suspect driver who eluded pursuit - The Outer Banks... |
| KDH Police seek information on suspect driver who eluded pursuit The Outer Banks Voice |
 "police" - Google News "police" - Google News | 48m | |
|
|
|
 | Uvalde school chief defends actions ahead of possible firing - WSAZ |
| Uvalde school chief defends actions ahead of possible firing WSAZ |
 "Robb Elementary Uvalde" - Google News "Robb Elementary Uvalde" - Google News | 1h | |
|
|
|
 | Uvalde school officials to discuss firing Pete Arredondo on Aug. 24 - The Texas Tribune |
| Uvalde school officials to discuss firing Pete Arredondo on Aug. 24 The Texas Tribune |
 "Robb Elementary Uvalde" - Google News "Robb Elementary Uvalde" - Google News | 1h | |
|
|
|
| Man Rubbed Genitals Against Mom Standing With Daughter On UWS: NYPD - Upper West... |
| Man Rubbed Genitals Against Mom Standing With Daughter On UWS: NYPD Upper West Side, NY Patch |
 "NYPD" - Google News "NYPD" - Google News | 1h | |
|
|
|
| Police officer fatally shoots man armed with knife, hammer in Waukegan: officials... |
| Police officer fatally shoots man armed with knife, hammer in Waukegan: officials Chicago Sun-Times |
 "police" - Google News "police" - Google News | 1h | |
|
|
|
| Police: 2 injured in West Ashley shooting - Live 5 News WCSC |
| Police: 2 injured in West Ashley shooting Live 5 News WCSC |
 "police" - Google News "police" - Google News | 1h | |
|
|
|
| McMinnville officers fatally shoot man who may have been suicidal, police say - OregonLive |
| McMinnville officers fatally shoot man who may have been suicidal, police say OregonLive |
 "police" - Google News "police" - Google News | 1h | |
|
|
|
| 'Hulk' actor sworn in as honorary N.Y. police officer - Police News |
| 'Hulk' actor sworn in as honorary N.Y. police officer Police News |
 "police" - Google News "police" - Google News | 1h | |
|
|
|
| Albuquerque police seek help in IDing woman found dead by train tracks - KOB 4 |
| Albuquerque police seek help in IDing woman found dead by train tracks KOB 4 |
 "police" - Google News "police" - Google News | 1h | |
|
|
|
| COLUMBUS POLICE INVESTIGATING FATAL SHOOTING - KWHI |
| COLUMBUS POLICE INVESTIGATING FATAL SHOOTING KWHI |
 "police" - Google News "police" - Google News | 1h | |
|
|
|
| Uvalde school board to consider firing district police chief - WSVN 7News | Miami... |
| Uvalde school board to consider firing district police chief WSVN 7News | Miami News, Weather, Sports... |
 "Robb Elementary Uvalde" - Google News "Robb Elementary Uvalde" - Google News | 1h | |
|
|
|
 | The 5 best ways to wipe out invasive spotted lanternflies |
| The plant-munching insects — which are native to China, with red and gray wings — are wreaking havoc... |
 NY Post: NYPD Blotter NY Post: NYPD Blotter | 1h | |
|
|
|
 | California set to ban sales of new gas-powered cars by 2035 |
| California regulators are set to ban the sale of new gasoline-powered cars by 2035 — a move that was... |
 NY Post: NYPD Blotter NY Post: NYPD Blotter | 1h | |
|
|
|
 | Courtney Boerner hopes 'Love Island USA' casts more bisexual contestants |
| "Incorporating more bi contestants would be really interesting," the sole queer star of Season 4 tells... |
 NY Post: NYPD Blotter NY Post: NYPD Blotter | 1h | |
|
|
|
 | 5 migrant buses mark the most ever to arrive in NYC from Texas in one day |
| City officials said latest the caravan carried a total of 237 passengers, including 14 children, all... |
 NY Post: NYPD Blotter NY Post: NYPD Blotter | 1h | |
|
|
|
 | Tiger Woods, Rory McIlroy launching TGL virtual golf league on Monday nights |
| The NFL playing on Monday nights helped transform football. Tiger Woods and Rory McIlroy hope it does... |
 NY Post: NYPD Blotter NY Post: NYPD Blotter | 1h | |
|
|
|
 | Stop telling critics to leave NY, Gov. Hochul — Dems have driven out too many already! |
| "Jump on a bus and head down to Florida where you belong," Gov. Kathy Hochul hectored her opponent Lee... |
 NY Post: NYPD Blotter NY Post: NYPD Blotter | 1h | |
|
|
|
 | Shameless feds leak details of Mar-a-Lago raid but push court to keep affidavit sealed |
| The feds have maintained that absolute secrecy is essential to protect their investigation and national... |
 NY Post: NYPD Blotter NY Post: NYPD Blotter | 1h | |
|
|
|
 | Ex-Jets coach Rex Ryan a contestant on 'The Amazing Race' |
| Rex Ryan is about to get hit with a dose of reality — TV, that is. |
 NY Post: NYPD Blotter NY Post: NYPD Blotter | 1h | |
|
|
|
 | Judge tosses suit from Jeffrey Epstein-linked building opposing NY Blood Center HQ |
| A judge tossed a suit by an NYC condo board — where Jeffrey Epstein's brother owns units — that opposed... |
 NY Post: NYPD Blotter NY Post: NYPD Blotter | 1h | |
|
|
|
 | Harvey Weinstein granted right to appeal by New York court |
| Convicted sex offender and catalyst for the #MeToo movement Harvey Weinstein has been granted the right... |
 NY Post: NYPD Blotter NY Post: NYPD Blotter | 1h | |
|
|
|
 | Jury begins deliberations in Vanessa Bryant's lawsuit over Kobe crash photos |
| "This is a pictures case but there are no pictures." |
 NY Post: NYPD Blotter NY Post: NYPD Blotter | 1h | |
|
|
|
 | Florida man on trial for attempting to murder, rape ex-wife axes lawyers and cross-examines... |
| The victim appeared badly shaken Wednesday after realizing that her tormentor was set to interrogate... |
 NY Post: NYPD Blotter NY Post: NYPD Blotter | 1h | |
|
|
|
 | Girl, 3, declared 'dead,' wakes up at her funeral — then dies again |
| The family of Camila Roxana Martinez Mendoza is accusing a hospital of negligence after preemptively... |
 NY Post: NYPD Blotter NY Post: NYPD Blotter | 1h | |
|
|
|
 | Mitch McConnell slams Biden's loan forgiveness plan as giveaway to 'elites' |
| McConnell called the student loan forgiveness plan a giveaway to "elites with higher salaries." |
 NY Post: NYPD Blotter NY Post: NYPD Blotter | 1h | |
|
|
|
 | Jacksonville State's Rich Rodriguez accuses Stephen F. Austin of spying on practice |
| Is there a college football Spygate scandal brewing down south? |
 NY Post: NYPD Blotter NY Post: NYPD Blotter | 1h | |
|
|
|
 | Pelosi flip-flops on Biden's student debt forgiveness plan after initial opposition |
| "People think that the president of the United States has the power for debt forgiveness," the House... |
 NY Post: NYPD Blotter NY Post: NYPD Blotter | 1h | |
|
|
|
 | Noah Schnapp: 'Stranger Things' directors were 'not loving' when the cast hit puberty |
| "I don't know what to tell you. My voice is dropping," the now-17-year-old told his elder. |
 NY Post: NYPD Blotter NY Post: NYPD Blotter | 1h | |
|
|
|
 | Brewers vs. Dodgers predictions: Picks for the National League's best team |
| Betting tonight's rubber match of the three-game set between the Dodgers and Brewers. |
 NY Post: NYPD Blotter NY Post: NYPD Blotter | 1h | |
|
|
|
| Off-Duty NYPD Officer Critically Hurt in Mugging; Police Say Suspects Wanted for... |
| Off-Duty NYPD Officer Critically Hurt in Mugging; Police Say Suspects Wanted for 19 Robberies NBC New... |
 "NYPD" - Google News "NYPD" - Google News | 1h | |
|
|
|
| Police: Man fatally shot in Manassas - The Washington Post |
| Police: Man fatally shot in Manassas The Washington Post |
 "police" - Google News "police" - Google News | 1h | |
|
|
|
| Police release new details in fatal downtown Charleston crash - Live 5 News WCSC |
| Police release new details in fatal downtown Charleston crash Live 5 News WCSC |
 "police" - Google News "police" - Google News | 1h | |
|
|
|
| Police: California Man Shoots, Kills Burglar in Gun Battle - U.S. News & World Report |
| Police: California Man Shoots, Kills Burglar in Gun Battle U.S. News & World Report |
 "police" - Google News "police" - Google News | 1h | |
|
|
|
| Police: Mother kills adult son, then herself in Bismarck - The Associated Press -... |
| Police: Mother kills adult son, then herself in Bismarck The Associated Press - en Español |
 "police" - Google News "police" - Google News | 1h | |
|
|
|
| Kenosha Police Officer Joshua Sylvester fired, accused of sexually assaulting woman... |
| Kenosha Police Officer Joshua Sylvester fired, accused of sexually assaulting woman in custody WLS-TV |
 "police" - Google News "police" - Google News | 1h | |
|
|
|
| MIDDAY MASS SHOOTING | Police searching for vehicle they say involved in shooting... |
| MIDDAY MASS SHOOTING | Police searching for vehicle they say involved in shooting Fox Baltimore |
 "police" - Google News "police" - Google News | 1h | |
|
|
|
| Fargo police seek help locating missing teen - INFORUM |
| Fargo police seek help locating missing teen INFORUM |
 "police" - Google News "police" - Google News | 1h | |
|
|
|
| Austin nonprofit giving away free bikes to Uvalde students - FOX 7 Austin |
| Austin nonprofit giving away free bikes to Uvalde students FOX 7 Austin |
 "Robb Elementary Uvalde" - Google News "Robb Elementary Uvalde" - Google News | 2h | |
|
|
|
| Off-duty officer in critical but stable condition after attack, police say - Spectrum... |
| Off-duty officer in critical but stable condition after attack, police say Spectrum News NY1 |
 "NYPD" - Google News "NYPD" - Google News | 2h | |
|
|
|
| Police investigating reported shooting of woman at Georgetown home - Austin American-Statesman |
| Police investigating reported shooting of woman at Georgetown home Austin American-Statesman |
 "police" - Google News "police" - Google News | 2h | |
|
|
|
| Akron Freedom BLOC delivers police reform petition civilian review board - Akron... |
| Akron Freedom BLOC delivers police reform petition civilian review board Akron Beacon Journal |
 "police" - Google News "police" - Google News | 2h | |
|
|
|
| Maryland Police Officer Indicted for Excessive Force and Witness Tampering - Department... |
| Maryland Police Officer Indicted for Excessive Force and Witness Tampering Department of Justice |
 "police" - Google News "police" - Google News | 2h | |
|
|
|
| Madison police make arrest in countywide string of burglaries - Channel3000.com -... |
| Madison police make arrest in countywide string of burglaries Channel3000.com - WISC-TV3 |
 "police" - Google News "police" - Google News | 2h | |
|
|
|
| Chicago police seek information on 3 suspects in Red Line robbery - CBS Chicago |
| Chicago police seek information on 3 suspects in Red Line robbery CBS Chicago |
 "police" - Google News "police" - Google News | 2h | |
|
|
|
| Police find parents of 4-year-old found alone in Clio - WJRT |
| Police find parents of 4-year-old found alone in Clio WJRT |
 "police" - Google News "police" - Google News | 2h | |
|
|
|
| Here's how the NYPD and a parole officer tracked down NYC 'sucker puncher' Bui Van... |
| Here's how the NYPD and a parole officer tracked down NYC 'sucker puncher' Bui Van Phu New York Post... |
 "NYPD" - Google News "NYPD" - Google News | 2h | |
|
|
|
| Southfield police want help finding missing 13-year-old boy - WDIV ClickOnDetroit |
| Southfield police want help finding missing 13-year-old boy WDIV ClickOnDetroit |
 "police" - Google News "police" - Google News | 2h | |
|
|
|
| Tulare police: 'Accidental' shooting kills Fresno County woman - Visalia Times-Delta... |
| Tulare police: 'Accidental' shooting kills Fresno County woman Visalia Times-Delta and Tulare Advance-Register |
 "police" - Google News "police" - Google News | 2h | |
|
|
|
| Tallahassee and FSU Police Departments Offer Tips for a Safe, Enjoyable Football... |
| Tallahassee and FSU Police Departments Offer Tips for a Safe, Enjoyable Football Game Day Experience Florida... |
 "police" - Google News "police" - Google News | 2h | |
|
|
|
| Motorcyclist dead after trying to go around traffic in emergency lane, police say... |
| Motorcyclist dead after trying to go around traffic in emergency lane, police say WKYT |
 "police" - Google News "police" - Google News | 2h | |
|
|
|
| Human remains found in Beaver Lake, police say - Fayetteville Flyer |
| Human remains found in Beaver Lake, police say Fayetteville Flyer |
 "police" - Google News "police" - Google News | 2h | |
|
|
|
| Submerged pickeup at Bridgeport Dam was stolen, police say, but details murky - TribLIVE |
| Submerged pickeup at Bridgeport Dam was stolen, police say, but details murky TribLIVE |
 "police" - Google News "police" - Google News | 2h | |
|
|
|
| Funeral service held for Miami-Dade police Detective Cesar 'Echy' Echaverry - WPLG... |
| Funeral service held for Miami-Dade police Detective Cesar 'Echy' Echaverry WPLG Local 10 |
 "police" - Google News "police" - Google News | 2h | |
|
|
|
| GET LIT POET - SIERRA LEONE ANDERSON - CRAFTS AN ORIGINAL POEM TITLED "FOR UVALDE"... |
| GET LIT POET - SIERRA LEONE ANDERSON - CRAFTS AN ORIGINAL POEM TITLED "FOR UVALDE" - REFLECTING ON THE... |
 "Robb Elementary Uvalde" - Google News "Robb Elementary Uvalde" - Google News | 3h | |
|
|
|
 | Chic Soho penthouse with massive roof terrace relists for $6.8M |
| Susan Vogel and Kenneth Prewitt share this Prince Street co-op -- with a magical rooftop garden -- that... |
 NY Post: NYPD Blotter NY Post: NYPD Blotter | 3h | |
|
|
|
 | Scott Disick dating Rod Stewart's daughter Kimberly |
| The "Flip It Like Disick" alum, 39, and model, 43, have been spotted hanging out together in Los Angeles... |
 NY Post: NYPD Blotter NY Post: NYPD Blotter | 3h | |
|
|
|
 | Black-belt male nurse who ran Florida jiu-jitsu school arrested for sexually assaulting... |
| According to reports, Gingery, who owns a jiu-jitsu studio in Ormond Beach, repeatedly called the woman... |
 NY Post: NYPD Blotter NY Post: NYPD Blotter | 3h | |
|
|
|
 | Michigan Belle Isle Park's Giant Slide goes viral after speed concerns |
| The Giant Slide was closed at Belle Isle Park in Michigan due to its potentially dangerous speed for... |
 NY Post: NYPD Blotter NY Post: NYPD Blotter | 3h | |
|
|
|
 | Royals vs. Diamondbacks prediction, MLB picks today: Zac Gallen on a tear |
| Zac Gallen against a feeble Royals offense is a recipe for betting success. |
 NY Post: NYPD Blotter NY Post: NYPD Blotter | 3h | |
|
|
|
 | 2022 Tour Championship picks: Best long shot bets to win at East Lake |
| Two long shot bets to target at the Tour Championship this weekend. |
 NY Post: NYPD Blotter NY Post: NYPD Blotter | 3h | |
|
|
|
 | Madonna’s daughter Lourdes Leon releases debut single ‘Lock&Key’ |
| Madonna's daughter, Lourdes Leon, released her debut musical single Wednesday — following in the footsteps... |
 NY Post: NYPD Blotter NY Post: NYPD Blotter | 3h | |
|
|
|
 | Listen to Episode 47 of 'Marchand and Ourand': ESPN's Burke Magnus on college sports |
| Burke Magnus discussed what happened during Big Ten media rights negotiations and how ESPN views upcoming... |
 NY Post: NYPD Blotter NY Post: NYPD Blotter | 3h | |
|
|
|
 | Maria Shriver looks unrecognizable while visiting new home in Santa Monica |
| The former first lady of California showed off a new look while paying a visit to the construction site... |
 NY Post: NYPD Blotter NY Post: NYPD Blotter | 3h | |
|
|
|
 | IRS to forgive $1.2 billion in late filing fees from COVID pandemic |
| Taxpayers must file any late returns by Sept. 30 of this year in order to qualify for forgiven late fees,... |
 NY Post: NYPD Blotter NY Post: NYPD Blotter | 3h | |
|
|
|
 | 'The Masked Singer' leans hard into Tom Brady rumors |
| Just when we thought we were out of the Tom Brady "Masked Singer" controversy, they pulled us back in. |
 NY Post: NYPD Blotter NY Post: NYPD Blotter | 3h | |
|
|
|
 | Olivia Wilde says Shia LaBeouf was fired from 'Don't Worry Darling' to keep Florence... |
| Director Olivia Wilde had a "no a--hole policy" on the set of the upcoming drama. |
 NY Post: NYPD Blotter NY Post: NYPD Blotter | 3h | |
|
|
|
 | 'Lord of The Rings' EPs Reveal There's No Last Second VFX Crunch: "It's All Done" |
| Amazon's big fantasy bet isn't still a work-in-progress. |
 NY Post: NYPD Blotter NY Post: NYPD Blotter | 3h | |
|
|
|
 | How Gayle King may have leaked details of her new CBS mega-contract |
| Gayle King revealed details of her new contract with CBS. |
 NY Post: NYPD Blotter NY Post: NYPD Blotter | 3h | |
|
|
|
 | Andy Roddick had 'no idea' he fathered Jan's child in 'The Office' script |
| The former world No. 1 tennis player said he didn't know "The Office" writers named him the father of... |
 NY Post: NYPD Blotter NY Post: NYPD Blotter | 3h | |
|
|
|
 | Stream It Or Skip It: 'Selling The OC' on Netflix, A 'Selling Sunset' Spinoff With... |
| Put on the ritz and pull out the drama for Selling the OC, a Selling Sunset spinoff with its own lux... |
 NY Post: NYPD Blotter NY Post: NYPD Blotter | 3h | |
|
|
|
 | Haunted hell: I work at 'The Conjuring' house, here's what it's like |
| Do you have what it takes to spend your days inside the Rhode Island home that inspired the 2013 film... |
 NY Post: NYPD Blotter NY Post: NYPD Blotter | 3h | |
|
|
|
 | Yankees 2023 schedule released: Opening Day vs. Giants |
| Though they have plenty to worry about at present, the Yankees' 2023 schedule is here. |
 NY Post: NYPD Blotter NY Post: NYPD Blotter | 3h | |
|
|
|
| Man faces charges in crash that paralyzed Kalamazoo police officer - WWMT-TV |
| Man faces charges in crash that paralyzed Kalamazoo police officer WWMT-TV |
 "police" - Google News "police" - Google News | 3h | |
|
|
|
| FedEx mistakenly delivered 30 rifles to high school, police said - The Seattle Times |
| FedEx mistakenly delivered 30 rifles to high school, police said The Seattle Times |
 "police" - Google News "police" - Google News | 3h | |
|
|
|
| WATCH: Video shows off-duty NYPD officer getting robbed and beaten in Bronx - Sportskeeda |
| WATCH: Video shows off-duty NYPD officer getting robbed and beaten in Bronx Sportskeeda |
 "NYPD" - Google News "NYPD" - Google News | 3h | |
|
|
|
| Suspected northern Michigan drug traffickers busted after police find meth in mail... |
| Suspected northern Michigan drug traffickers busted after police find meth in mail FOX 2 Detroit |
 "police" - Google News "police" - Google News | 3h | |
|
|
|
| Police: Mother Kills Adult Son, Then Herself in Bismarck - U.S. News & World Report |
| Police: Mother Kills Adult Son, Then Herself in Bismarck U.S. News & World Report |
 "police" - Google News "police" - Google News | 3h | |
|
|
|
| Petaluma daughter lives with mother's corpse for more than a year: police - FOX 29... |
| Petaluma daughter lives with mother's corpse for more than a year: police FOX 29 Philadelphia |
 "police" - Google News "police" - Google News | 3h | |
|
|
|
| Appeals Court Upholds DC Law Reforming Police Discipline - DCist |
| Appeals Court Upholds DC Law Reforming Police Discipline DCist |
 "police" - Google News "police" - Google News | 3h | |
|
|
|
| Police confirm 2 missing men found safe in Jackson - WBBJ TV - WBBJ-TV |
| Police confirm 2 missing men found safe in Jackson - WBBJ TV WBBJ-TV |
 "police" - Google News "police" - Google News | 3h | |
|
|
|
| MSHP identifies man killed by Blue Springs police after firing at officers - KSHB... |
| MSHP identifies man killed by Blue Springs police after firing at officers KSHB 41 Kansas City News |
 "police" - Google News "police" - Google News | 3h | |
|
|
|
| Police detective's false testimony ignites latest flash of controversy in high-profile... |
| Police detective's false testimony ignites latest flash of controversy in high-profile Kansas trial Kansas... |
 "police" - Google News "police" - Google News | 3h | |
|
|
|
| Police investigation underway in Carter County - WCYB |
| Police investigation underway in Carter County WCYB |
 "police" - Google News "police" - Google News | 3h | |
|
|
|
| Las Vegas police: Impairment suspected after driver killed, child injured in single-vehicle... |
| Las Vegas police: Impairment suspected after driver killed, child injured in single-vehicle crash Fox... |
 "police" - Google News "police" - Google News | 3h | |
|
|
|
 | Seriously? Private school affirms 13-year-old girl's identify as a cat, calls her... |
| The following includes content which is editorial in nature and reflects the opinion of the writer. ... |
 Law Enforcement Today Law Enforcement Today | 4h | |
|
|
|
| Chandler police seizure hundreds of fentanyl pills, meth during traffic stop - Arizona's... |
| Chandler police seizure hundreds of fentanyl pills, meth during traffic stop Arizona's Family |
 "police" - Google News "police" - Google News | 4h | |
|
|
|
| Conway police searching for vehicle in reported road rage incident - WMBF |
| Conway police searching for vehicle in reported road rage incident WMBF |
 "police" - Google News "police" - Google News | 4h | |
|
|
|
| Bismarck police investigate suspected murder-suicide - KFYR |
| Bismarck police investigate suspected murder-suicide KFYR |
 "police" - Google News "police" - Google News | 4h | |
|
|
|
| Police Log: August 24, 2022 - WBIW.com |
| Police Log: August 24, 2022 WBIW.com |
 "police" - Google News "police" - Google News | 4h | |
|
|
|
| 8th and Manitoba shooting; appears road rage related: police - FOX 6 Milwaukee |
| 8th and Manitoba shooting; appears road rage related: police FOX 6 Milwaukee |
 "police" - Google News "police" - Google News | 4h | |
|
|
|
| Uvalde schools, law enforcement could face $27B class-action suit - Salina Post |
| Uvalde schools, law enforcement could face $27B class-action suit Salina Post |
 "Robb Elementary Uvalde" - Google News "Robb Elementary Uvalde" - Google News | 4h | |
|
|
|
 | Kelli Giddish, Rollins on ‘Law & Order: SVU,’ to Exit Show in Season... |
| Pour one out for Carisi. |
 NY Post: NYPD Blotter NY Post: NYPD Blotter | 4h | |
|
|
|
 | Stream It Or Skip It: 'Running with the Devil: The Wild World of John McAfee' on... |
| In which we spend a lot of time with an intensely agitating man. |
 NY Post: NYPD Blotter NY Post: NYPD Blotter | 4h | |
|
|
|
 | Mets star Francisco Lindor eyes $18 million penthouse |
| We hear the shortstop, who has a $341 million contract with the Mets, was spotted checking out an apartment... |
 NY Post: NYPD Blotter NY Post: NYPD Blotter | 4h | |
|
|
|
 | Uvalde shooting victims' families could sue school, police for $27 billion |
| The lawyers representing the nine victims' families that are part of the claim hope to reach a settlement... |
 NY Post: NYPD Blotter NY Post: NYPD Blotter | 4h | |
|
|
|
| The gross reason you should skip using electric hand dryers |
| Electric hand dryers are eco-friendly — but may hide a dirty secret. |
 NY Post: NYPD Blotter NY Post: NYPD Blotter | 4h | |
|
|
|
 | Pro biker Rab Wardell dead at 37, two days after winning championship |
| Wardell's girlfriend, Olympic cycling medalist Katie Archibald, said Wardell went into cardiac arrest... |
 NY Post: NYPD Blotter NY Post: NYPD Blotter | 4h | |
|
|
|
 | Rachael Kirkconnell blasts sports announcer who called Matt James single |
| Kirkconnell and James met on Season 25 of "The Bachelor." The duo were together when the show wrapped... |
 NY Post: NYPD Blotter NY Post: NYPD Blotter | 4h | |
|
|
|
 | Is traveling worth the pain? Over one-third of Americans get aches from travel: poll |
| More than one-third of Americans agree that soreness associated with travel has stopped them from going... |
 NY Post: NYPD Blotter NY Post: NYPD Blotter | 4h | |
|
|
|
 | Diamonds and cashmere: I let Sutton Stracke style me like a 'Housewife' |
| Sutton took pity on me (and my wardrobe) and styled me for a boozy brunch, tropical cast trip and reunion... |
 NY Post: NYPD Blotter NY Post: NYPD Blotter | 4h | |
|
|
|
 | Airwrap dupe? Preorder the new Shark FlexStyle hair dryer brush now |
| Get your hands on this must-have hair styler now. |
 NY Post: NYPD Blotter NY Post: NYPD Blotter | 4h | |
|
|
|
 | Facebook reveals cause of bizarre celebrity spam glitch |
| The posts ranged from text replies to photos and weird memes. |
 NY Post: NYPD Blotter NY Post: NYPD Blotter | 4h | |
|
|
|
 | What Time Will 'She-Hulk: Attorney at Law' Episode 2 Be on Disney+? |
| C'mon, who doesn't love Tatiana Maslany? |
 NY Post: NYPD Blotter NY Post: NYPD Blotter | 4h | |
|
|
|
 | 2022 Tour Championship: First-round leader picks and odds |
| First-round leader picks for the 2022 Tour Championship. |
 NY Post: NYPD Blotter NY Post: NYPD Blotter | 4h | |
|
|
|
 | Moment horrified motel guests discovered Hellen Nyabuto's body in pool water |
| Visitors at the Key Motel in Chatsworth, Ontario got a grisly surprise when they waded into the body... |
 NY Post: NYPD Blotter NY Post: NYPD Blotter | 4h | |
|
|
|
 | I'm a 'girly girl' who works construction — men say I'm 'too pretty' for it |
| Women have long been part of the construction industry, but it's not everyday you see one hair extensions... |
 NY Post: NYPD Blotter NY Post: NYPD Blotter | 4h | |
|
|
|
 | Rihanna pairs oversized football jersey with clogs on date with A$AP Rocky |
| The bad gal delivered during a recent errands run, rocking checkered pants, an oversized vintage TLC... |
 NY Post: NYPD Blotter NY Post: NYPD Blotter | 4h | |
|
|
|
 | Who Is Penny in 'Top Gun: Maverick'? Meet Jennifer Connelly's Character |
| Charlie who? |
 NY Post: NYPD Blotter NY Post: NYPD Blotter | 4h | |
|
|
|
 | 'Spiritual psychologist' tattoos eye on forehead for 'instant enlightenment' |
| A self-described "spiritual psychologist" recently claimed he tattooed an eye in the middle of his forehead,... |
 NY Post: NYPD Blotter NY Post: NYPD Blotter | 4h | |
|
|
|
 | Stephen A. Smith rants about player 'entitlement' after Nets' Kevin Durant saga ends |
| Stephen A. Smith emphasized that the Nets debacle this offseason has set NBA players back for "decades."... |
 NY Post: NYPD Blotter NY Post: NYPD Blotter | 4h | |
|
|
|
| Suspects in Skull-Cracking Bronx Mugging of Off-Duty Cop Wanted for 19 Robberies:... |
| Suspects in Skull-Cracking Bronx Mugging of Off-Duty Cop Wanted for 19 Robberies: NYPD NBC New York |
 "NYPD" - Google News "NYPD" - Google News | 4h | |
|
|
|
 | The feds have found a new way of targeting police officers in the death of Breonna... |
| LOUISVILLE, KY- According to reports, a former Louisville Metro Police Department (LMPD) detective has... |
 Law Enforcement Today Law Enforcement Today | 4h | |
|
|
|
 | Preparing for riots? Charges dropped against Atlanta officers in the fatal shooting... |
| ATLANTA, GA – According to several reports, authorities have announced that the charges against the two... |
 Law Enforcement Today Law Enforcement Today | 4h | |
|
|
|
| Police shooting of Dante Kittrell ruled justified; no criminal charges to be filed... |
| Police shooting of Dante Kittrell ruled justified; no criminal charges to be filed South Bend Tribune |
 "police" - Google News "police" - Google News | 5h | |
|
|
|
| Police warn public of vehicle theft scam in Vancouver - Fox 12 Oregon |
| Police warn public of vehicle theft scam in Vancouver Fox 12 Oregon |
 "police" - Google News "police" - Google News | 5h | |
|
|
|
| Fort Lauderdale man stabs victim to 'point of near amputation,' police say - WPLG... |
| Fort Lauderdale man stabs victim to 'point of near amputation,' police say WPLG Local 10 |
 "police" - Google News "police" - Google News | 5h | |
|
|
|
| Maryland State Police Investigating Possible Road Rage Shooting On I-83 In Baltimore... |
| Maryland State Police Investigating Possible Road Rage Shooting On I-83 In Baltimore County maryland.gov |
 "police" - Google News "police" - Google News | 5h | |
|
|
|
| Fatal shooting suspects believed to be in Lafayette area, Bogalusa police say - FOX... |
| Fatal shooting suspects believed to be in Lafayette area, Bogalusa police say FOX 8 Local First |
 "police" - Google News "police" - Google News | 5h | |
|
|
|
| Western Pa. high school football program pauses season as police investigate hazing... |
| Western Pa. high school football program pauses season as police investigate hazing incident PennLive |
 "police" - Google News "police" - Google News | 5h | |
|
|
|
| NYPD cops ordered not to 'congregate' or converse on city streets, memo shows - New... |
| NYPD cops ordered not to 'congregate' or converse on city streets, memo shows New York Post |
 "NYPD" - Google News "NYPD" - Google News | 5h | |
|
|
|
| New NYPD inspector general loses job before starting amid sexual harassment allegations... |
| New NYPD inspector general loses job before starting amid sexual harassment allegations New York Daily... |
 "NYPD" - Google News "NYPD" - Google News | 5h | |
|
|
|
| Worcester police to host first-ever Back to School Bash Saturday at Institute Park... |
| Worcester police to host first-ever Back to School Bash Saturday at Institute Park Worcester Telegram |
 "police" - Google News "police" - Google News | 5h | |
|
|
|
| Man charged in Atlanta shooting that wounded toddler at stoplight, police say - FOX... |
| Man charged in Atlanta shooting that wounded toddler at stoplight, police say FOX 5 Atlanta |
 "police" - Google News "police" - Google News | 5h | |
|
|
|
| Uvalde school board to decide whether to fire its police chief - Reuters |
| Uvalde school board to decide whether to fire its police chief Reuters |
 "police" - Google News "police" - Google News | 5h | |
|
|
|
| Knoxville police arrest two after they steal car from dealership, report says - WVLT |
| Knoxville police arrest two after they steal car from dealership, report says WVLT |
 "police" - Google News "police" - Google News | 5h | |
|
|
|
| Westborough police log, Aug. 26 edition - Community Advocate |
| Westborough police log, Aug. 26 edition Community Advocate |
 "police" - Google News "police" - Google News | 5h | |
|
|
|
| Manlius Center Road closed after crash that hospitalized one, police say - syracuse.com |
| Manlius Center Road closed after crash that hospitalized one, police say syracuse.com |
 "police" - Google News "police" - Google News | 5h | |
|
|
|
| Police investigate daylight assault in Boston Common - Boston.com |
| Police investigate daylight assault in Boston Common Boston.com |
 "police" - Google News "police" - Google News | 5h | |
|
|
|
| Traffic cameras capture dramatic police chase in Minneapolis - CBS News |
| Traffic cameras capture dramatic police chase in Minneapolis CBS News |
 "police" - Google News "police" - Google News | 5h | |
|
|
|
| Pryor police searching for murder suspect - KTUL |
| Pryor police searching for murder suspect KTUL |
 "police" - Google News "police" - Google News | 5h | |
|
|
|
| Minneapolis Police Department plans to purchase drones - MPR News |
| Minneapolis Police Department plans to purchase drones MPR News |
 "police" - Google News "police" - Google News | 5h | |
|
|
|
| Robb Elementary principal pushes back against allegations of lax security at school... |
| Robb Elementary principal pushes back against allegations of lax security at school KHOU.com |
 "Robb Elementary Uvalde" - Google News "Robb Elementary Uvalde" - Google News | 5h | |
|
|
|
| Artists come together for Uvalde 'Healing Murals' project - Laredo Morning Times |
| Artists come together for Uvalde 'Healing Murals' project Laredo Morning Times |
 "Robb Elementary Uvalde" - Google News "Robb Elementary Uvalde" - Google News | 5h | |
|
|
|
| Former Hollywood police officer on trial over battery testifies in Broward court... |
| Former Hollywood police officer on trial over battery testifies in Broward court WPLG Local 10 |
 "police" - Google News "police" - Google News | 6h | |
|
|
|
| Rep. Marjorie Taylor Greene targeted in 'swatting' incident, police say - CNN |
| Rep. Marjorie Taylor Greene targeted in 'swatting' incident, police say CNN |
 "police" - Google News "police" - Google News | 6h | |
|
|
|
| Police: Man shot to death after answering his apartment door in Mercer County - FOX... |
| Police: Man shot to death after answering his apartment door in Mercer County FOX 29 Philadelphia |
 "police" - Google News "police" - Google News | 6h | |
|
|
|
| Police search for suspects in Short Pump grand larcenies - WWBT |
| Police search for suspects in Short Pump grand larcenies WWBT |
 "police" - Google News "police" - Google News | 6h | |
|
|
|
| Las Vegas police ask for help locating missing 75-year-old man - Fox 5 Las Vegas |
| Las Vegas police ask for help locating missing 75-year-old man Fox 5 Las Vegas |
 "police" - Google News "police" - Google News | 6h | |
|
|
|
| Nederland marshal resigns as future of town's police department remains uncertain... |
| Nederland marshal resigns as future of town's police department remains uncertain Boulder Daily Camera |
 "police" - Google News "police" - Google News | 6h | |
|
|
|
| What's going on with the Minneapolis Police Conduct Oversight Commission? - MinnPost |
| What's going on with the Minneapolis Police Conduct Oversight Commission? MinnPost |
 "police" - Google News "police" - Google News | 6h | |
|
|
|
| Novato police arrest teen, cite 2 others after knifepoint robbery - Marin Independent... |
| Novato police arrest teen, cite 2 others after knifepoint robbery Marin Independent Journal |
 "police" - Google News "police" - Google News | 6h | |
|
|
|
| Uvalde Funeral Homes Refused Services For Robb Elementary School Shooter - iHeart |
| Uvalde Funeral Homes Refused Services For Robb Elementary School Shooter iHeart |
 "Robb Elementary Uvalde" - Google News "Robb Elementary Uvalde" - Google News | 6h | |
|
|
|
| Uvalde school board to consider firing district police chief - WWNY |
| Uvalde school board to consider firing district police chief WWNY |
 "Robb Elementary Uvalde" - Google News "Robb Elementary Uvalde" - Google News | 6h | |
|
|
|
 | Man ripped after brutal break-up reminder goes viral |
| Footage of the man was posted to TikTok after radio host Emma Chow spotted him on her train carriage... |
 NY Post: NYPD Blotter NY Post: NYPD Blotter | 6h | |
|
|
|
 | Pennsylvania Senate race turns into veggie fight after Dr. Oz crudité video |
| The crack came after Pennsylvania Lt. Gov. John Fetterman mocked a video Dr. Mehmet Oz released earlier... |
 NY Post: NYPD Blotter NY Post: NYPD Blotter | 6h | |
|
|
|
 | The supposedly racist incident at the Little League World Series and the surprising... |
| Talk about a nothing burger. |
 NY Post: NYPD Blotter NY Post: NYPD Blotter | 6h | |
|
|
|
 | Jack Russell saves owner from bear attack with some 'ninja moves' |
| Susan Lee, 61, was walking on her property in rural Vermont when a mama bear charged and bit her, but... |
 NY Post: NYPD Blotter NY Post: NYPD Blotter | 6h | |
|
|
|
 | Jair Bolsonaro celebrates Brazil's independence with embalmed heart of Portuguese... |
| The 200-year-old embalmed heart of Pedro I is suspended in formaldehyde inside a golden jar. |
 NY Post: NYPD Blotter NY Post: NYPD Blotter | 6h | |
|
|
|
 | Dad of 3 dies from cancer after hospital lost test results |
| After an investigation found that he may have survived if he learned of his tumor and was operated on... |
 NY Post: NYPD Blotter NY Post: NYPD Blotter | 6h | |
|
|
|
 | First lady Jill Biden tests positive for COVID in apparent rebound case |
| First lady Jill Biden has once again tested positive for COVID-19 in an apparent "rebound" case, her... |
 NY Post: NYPD Blotter NY Post: NYPD Blotter | 6h | |
|
|
|
 | Kim Kardashian defeats Hillary Clinton in round of legal trivia |
| The former U.S. Secretary of State lost to Kardashian, who passed California's "baby bar" exam in December... |
 NY Post: NYPD Blotter NY Post: NYPD Blotter | 6h | |
|
|
|
 | CNN's Jake Tapper sparks Twitter outrage after sharing Salena Zito story: 'He drank... |
| "Zito: Oz cannot out-meme Fetterman, but he can out-work and defeat him," Tapper tweeted, quoting the... |
 NY Post: NYPD Blotter NY Post: NYPD Blotter | 6h | |
|
|
|
 | Shakira fans speculate if girlfriend of her ex, Gerard Piqué, dances to pop star's... |
| The fallout from Shakira's breakup with longtime beau Gerard Piqué has taken a bizarre new turn. |
 NY Post: NYPD Blotter NY Post: NYPD Blotter | 6h | |
|
|
|
 | Influencer Kat Kalamani in tears after daughter was rejected by her friends |
| 'I haven't stopped crying since my daughter was rejected by her friends' |
 NY Post: NYPD Blotter NY Post: NYPD Blotter | 6h | |
|
|
|
 | Wild video shows Florida carjacker get hit by police car after sprawling chase |
| The suspect led police on a 30-minute chase before finally hopping out of the stolen box truck and running... |
 NY Post: NYPD Blotter NY Post: NYPD Blotter | 6h | |
|
|
|
 | Stolen car gets stuck going up subway stairs |
| Firefighters had an uphill battle in Madrid, Spain, removing a white Mazda stuck on the stairs of a subway... |
 NY Post: NYPD Blotter NY Post: NYPD Blotter | 6h | |
|
|
|
 | Miami Zoo shows X-ray of cottonmouth snake that swallowed Burmese python |
| The Miami Zoo posted a photo of the amazing x-ray on its Facebook account. |
 NY Post: NYPD Blotter NY Post: NYPD Blotter | 6h | |
|
|
|
 | Madonna's daughter Lourdes wears nothing but ropes in debut music video |
| The 25-year-old star dropped her first single, "Lock&Key," on Wednesday — along with a sultry music... |
 NY Post: NYPD Blotter NY Post: NYPD Blotter | 6h | |
|
|
|
 | Chelsea Clinton: I deleted Kanye West music to support Kim Kardashian |
| "Just the way that he has treated Kim Kardashian, the way that he has talked about women is unconscionable... |
 NY Post: NYPD Blotter NY Post: NYPD Blotter | 6h | |
|
|
|
 | I spent $70K on plastic surgery to look like a Ken doll — and I want more |
| A self-proclaimed "human Ken doll" has spent about $70,000 on cosmetic surgeries to achieve his "fake"... |
 NY Post: NYPD Blotter NY Post: NYPD Blotter | 6h | |
|
|
|
 | Twitter CEO tells staff whistleblower claims are 'inaccurate' |
| Twitter General Counsel Sean Edgett also told employees the company reached out proactively to various... |
 NY Post: NYPD Blotter NY Post: NYPD Blotter | 6h | |
|
|
|
 | Peloton to sell exercise bikes, accessories on Amazon |
| Pelton shares soared on the news although the stock has lost more than half of its value this year. |
 NY Post: NYPD Blotter NY Post: NYPD Blotter | 6h | |
|
|
|
 | Olivia Wilde denies Harry Styles got triple Florence Pugh's salary for new film |
| The "Don't Worry Darling" director quelled speculation her leading man-turned-boyfriend was paid more... |
 NY Post: NYPD Blotter NY Post: NYPD Blotter | 6h | |
|
|
|
| NYPD: ATV in Deadly Crash was Stolen - Western Queens Gazette |
| NYPD: ATV in Deadly Crash was Stolen Western Queens Gazette |
 "NYPD" - Google News "NYPD" - Google News | 6h | |
|
|
|
| VIDEO: Crooks wanted for critically injuring off-duty NYPD cop behind long violent... |
| VIDEO: Crooks wanted for critically injuring off-duty NYPD cop behind long violent carjacking and robbery... |
 "NYPD" - Google News "NYPD" - Google News | 6h | |
|
|
|
| Man Shot Trying To Stop Upper West Side Deli Robbery: NYPD - Patch |
| Man Shot Trying To Stop Upper West Side Deli Robbery: NYPD Patch |
 "NYPD" - Google News "NYPD" - Google News | 6h | |
|
|
|
| State police Sgt. Todd Girouard on restricted duty following off-duty drunken driving... |
| State police Sgt. Todd Girouard on restricted duty following off-duty drunken driving arrest in West... |
 "police" - Google News "police" - Google News | 6h | |
|
|
|
| Police: Suspect shot with own gun after victim gains control during attempted robbery... |
| Police: Suspect shot with own gun after victim gains control during attempted robbery in Philadelphia... |
 "police" - Google News "police" - Google News | 6h | |
|
|
|
| Eric Smith officially sworn in as Orlando’s new police chief - WKMG News 6... |
| Eric Smith officially sworn in as Orlando's new police chief WKMG News 6 & ClickOrlando |
 "police" - Google News "police" - Google News | 6h | |
|
|
|
| Bryan Police arrest two suspected drug dealers, seize more than 60 pounds of drugs... |
| Bryan Police arrest two suspected drug dealers, seize more than 60 pounds of drugs KBTX |
 "police" - Google News "police" - Google News | 6h | |
|
|
|
| Police ID victim; 1 dead, 1 injured in BR shooting, police say - WAFB |
| Police ID victim; 1 dead, 1 injured in BR shooting, police say WAFB |
 "police" - Google News "police" - Google News | 6h | |
|
|
|
| Grafton police log, Aug. 26 edition - Community Advocate |
| Grafton police log, Aug. 26 edition Community Advocate |
 "police" - Google News "police" - Google News | 6h | |
|
|
|
| Resident shoots, kills suspect trying to get into Riverside apartment: Police - KTLA... |
| Resident shoots, kills suspect trying to get into Riverside apartment: Police KTLA Los Angeles |
 "police" - Google News "police" - Google News | 6h | |
|
|
|
| Heavy police presence along North Bailey Avenue - WKBW 7 News Buffalo |
| Heavy police presence along North Bailey Avenue WKBW 7 News Buffalo |
 "police" - Google News "police" - Google News | 6h | |
|
|
|
| 'Punish them': Wife of off-duty NYPD cop mugged in the Bronx begs for 'justice' -... |
| 'Punish them': Wife of off-duty NYPD cop mugged in the Bronx begs for 'justice' New York Post |
 "NYPD" - Google News "NYPD" - Google News | 6h | |
|
|
|
| VIDEO: Bronx robbery pair who ambushed 3 men sought by NYPD - 1010 WINS |
| VIDEO: Bronx robbery pair who ambushed 3 men sought by NYPD 1010 WINS |
 "NYPD" - Google News "NYPD" - Google News | 6h | |
|
|
|
| Group chases 13-year-old off Staten Island bus, takes his yarmulke, police say; being... |
| Group chases 13-year-old off Staten Island bus, takes his yarmulke, police say; being investigated as... |
 "NYPD" - Google News "NYPD" - Google News | 6h | |
|
|
|
| Police searching for robbery suspect who allegedly beat store clerk with baseball... |
| Police searching for robbery suspect who allegedly beat store clerk with baseball bat in Greater Fifth... |
 "police" - Google News "police" - Google News | 7h | |
|
|
|
| Police investigating Tuesday morning carjacking in Mount Pleasant - Live 5 News WCSC |
| Police investigating Tuesday morning carjacking in Mount Pleasant Live 5 News WCSC |
 "police" - Google News "police" - Google News | 7h | |
|
|
|
| Video shows Marin police officer dropping homeless person off in SF - SFGATE |
| Video shows Marin police officer dropping homeless person off in SF SFGATE |
 "police" - Google News "police" - Google News | 7h | |
|
|
|
| Akron police arrest man accused of murdering a 34-year-old mother - Cleveland 19... |
| Akron police arrest man accused of murdering a 34-year-old mother Cleveland 19 News |
 "police" - Google News "police" - Google News | 7h | |
|
|
|
| Officer charged in 2020 death of Moline Acres Police Sergeant - KTVI Fox 2 St. Louis |
| Officer charged in 2020 death of Moline Acres Police Sergeant KTVI Fox 2 St. Louis |
 "police" - Google News "police" - Google News | 7h | |
|
|
|
| Woman calls police about stolen property, forgets to mention she's carrying drugs:... |
| Woman calls police about stolen property, forgets to mention she's carrying drugs: Parma Heights Police... |
 "police" - Google News "police" - Google News | 7h | |
|
|
|
| Kokomo woman charged after police say she left 4 children at home to go shopping... |
| Kokomo woman charged after police say she left 4 children at home to go shopping in Indianapolis FOX... |
 "police" - Google News "police" - Google News | 7h | |
|
|
|
| Police: NC man suspected of stabbing wife to death killed in car wreck 30 minutes... |
| Police: NC man suspected of stabbing wife to death killed in car wreck 30 minutes later WGHP FOX8 Greensboro |
 "police" - Google News "police" - Google News | 7h | |
|
|
|
| Police search for suspects after two-county pursuit that reached speeds up to 105... |
| Police search for suspects after two-county pursuit that reached speeds up to 105 mph WCHS |
 "police" - Google News "police" - Google News | 7h | |
|
|
|
| City police calls – Aug. 24 - The Republic |
| City police calls – Aug. 24 The Republic |
 "police" - Google News "police" - Google News | 7h | |
|
|
|
| Uvalde school board to consider firing district police chief - The Columbian |
| Uvalde school board to consider firing district police chief The Columbian |
 "Robb Elementary Uvalde" - Google News "Robb Elementary Uvalde" - Google News | 7h | |
|
|
|
| GET LIT POET - SIERRA LEONE ANDERSON - CRAFTS AN ORIGINAL POEM TITLED "FOR UVALDE"... |
| GET LIT POET - SIERRA LEONE ANDERSON - CRAFTS AN ORIGINAL POEM TITLED "FOR UVALDE" - REFLECTING ON THE... |
 "Robb Elementary Uvalde" - Google News "Robb Elementary Uvalde" - Google News | 7h | |
|
|
|
| Detroit Police Vehicle Auction - AC's Towing - 9-6-2022 - City of Detroit |
| Detroit Police Vehicle Auction - AC's Towing - 9-6-2022 City of Detroit |
 "police" - Google News "police" - Google News | 7h | |
|
|
|
| Police conducting criminal investigation along Bach Lane in South Hadley - Western... |
| Police conducting criminal investigation along Bach Lane in South Hadley Western Massachusetts News |
 "police" - Google News "police" - Google News | 7h | |
|
|
|
| Police investigating 'swatting' call directed at Marjorie Taylor Greene's home -... |
| Police investigating 'swatting' call directed at Marjorie Taylor Greene's home The Hill |
 "police" - Google News "police" - Google News | 7h | |
|
|
|
| FedEx mistakenly delivered 30 rifles to Chester High School, police said - The Philadelphia... |
| FedEx mistakenly delivered 30 rifles to Chester High School, police said The Philadelphia Inquirer |
 "police" - Google News "police" - Google News | 7h | |
|
|
|
| Rochester Police investigate overnight shooting on Pierpont Street - 13WHAM-TV |
| Rochester Police investigate overnight shooting on Pierpont Street 13WHAM-TV |
 "police" - Google News "police" - Google News | 7h | |
|
|
|
 | Spike in fentanyl overdoses leads US morgues to run out of space |
| Coroner's offices across the country say it's tough to keep up with the bodies piling up. |
 NY Post: NYPD Blotter NY Post: NYPD Blotter | 7h | |
|
|
|
 | My Chemical Romance's Gerard Way rocks cheerleader dress during concert |
| Fans praised the frontman, who wrote about their "gender identity issues" in 2015, for "embracing his... |
 NY Post: NYPD Blotter NY Post: NYPD Blotter | 7h | |
|
|
|
 | Kentucky school official compares parent to Hitler in 'Gender Queer' book clash |
| A Kentucky media specialist insisted a book that contained sex imagery should be taught to kids—which... |
 NY Post: NYPD Blotter NY Post: NYPD Blotter | 7h | |
|
|
|
 | NBC, Bravo Programming Officially Leaving Hulu for Peacock, as Peacock Offers 60%... |
| Peacock is dramatically cutting its Premium pricing, but the sweet deal won't last forever. |
 NY Post: NYPD Blotter NY Post: NYPD Blotter | 7h | |
|
|
|
 | Capitol Records severs ties with 'virtual rapper' FN Meka after N-word controversy |
| "We cannot let robots say n—-a in any form," the diss track goes. "If we let robots say n—-a, that's... |
 NY Post: NYPD Blotter NY Post: NYPD Blotter | 7h | |
|
|
|
 | We built a cottage in our backyard and shipped it to the Bahamas |
| After becoming infatuated with the Bahamian island of Eleuthera, Miami architects Brillhart Architecture... |
 NY Post: NYPD Blotter NY Post: NYPD Blotter | 7h | |
|
|
|
 | 'Boyfriend haul' TikTok trend called out as 'racist,' compared to slave auctions |
| Be sure to read the reviews before buying into this disturbing trend. Yet another eyebrow-raising TikTok... |
 NY Post: NYPD Blotter NY Post: NYPD Blotter | 7h | |
|
|
|
 | Haunting video appears to show Jetal Agnihotri being swept to her death in Zion National... |
| The Tucson tourist's body was finally found Monday, about 6 miles south of where she had been swept away... |
 NY Post: NYPD Blotter NY Post: NYPD Blotter | 7h | |
|
|
|
 | Stream It Or Skip It: 'Mo' On Netflix, Where A Palestinian Refugee Lives In Houston,... |
| Mo Amer stars in the series, which he created with Ramy Youssef. |
 NY Post: NYPD Blotter NY Post: NYPD Blotter | 7h | |
|
|
|
 | 'Austin Powers 4'? Mike Myers Teases Possible Shagadelic Sequel on 'Kelly and Ryan' |
| Yeah, baby! |
 NY Post: NYPD Blotter NY Post: NYPD Blotter | 7h | |
|
|
|
 | How sisters Kat and Isabelle Shee are looking to 'stand out' among golf influencers |
| When Isabelle Shee joined forces with her younger sister Kat on social media two years ago, the longtime... |
 NY Post: NYPD Blotter NY Post: NYPD Blotter | 7h | |
|
|
|
 | Supermodel Bella Hadid pleads for 'rescue' of abused NYC carriage horse |
| Supermodel Bella Hadid is asking for donations for Ryder, the New York City carriage horse that collapsed... |
 NY Post: NYPD Blotter NY Post: NYPD Blotter | 7h | |
|
|
|
 | The best hair wavers of 2022: 10 tools for mermaid hair |
| No ocean required. |
 NY Post: NYPD Blotter NY Post: NYPD Blotter | 7h | |
|
|
|
 | Demi Lovato claims she was 'controlled' and 'brainwashed' by management |
| The Disney alum, who previously struggled with substance abuse, claims things got so bad with her eating... |
 NY Post: NYPD Blotter NY Post: NYPD Blotter | 7h | |
|
|
|
 | Hungarian weather official Kornelia Radics fired for 'inaccurate' forecast |
| On Monday, two top Hungarian officials were fired after a weather forecast for an important event in... |
 NY Post: NYPD Blotter NY Post: NYPD Blotter | 7h | |
|
|
|
 | Ex-Russian mayor and Putin critic arrested for slamming Ukraine war |
| Yevgeny Roizman, the popular former mayor of Yekaterinburg, was arrested on Wednesday on a charge of... |
 NY Post: NYPD Blotter NY Post: NYPD Blotter | 7h | |
|
|
|
 | Nikola Jokic, Boban Marjanovic party in wild new video from birthday bash |
| The Serbian hoopsters were seen living it up at the Lafayette Cuisine Club in Beograd as part of Bogdan... |
 NY Post: NYPD Blotter NY Post: NYPD Blotter | 7h | |
|
|
|
 | Texas church ordered to pay damages for illegal 'Hamilton' production |
| The production — dubbed "Scamilton" on Twitter — first made headlines when a video of Pastor Roman Gutierrez... |
 NY Post: NYPD Blotter NY Post: NYPD Blotter | 7h | |
|
|
|
 | Twitter reiterates spam accounts fewer than 5% in response to SEC |
| The filing comes ahead of a highly watched legal showdown between Twitter and Elon Musk. |
 NY Post: NYPD Blotter NY Post: NYPD Blotter | 7h | |
|
|
|
| Uvalde school board to consider firing district police chief – WABE - WABE 90.1 FM |
| Uvalde school board to consider firing district police chief – WABE WABE 90.1 FM |
 "Robb Elementary Uvalde" - Google News "Robb Elementary Uvalde" - Google News | 7h | |
|
|
|
| NYPD To Brooklyn Man: Your 311 Illegal Parking Complaints Are 'Wasting Our Time'... |
| NYPD To Brooklyn Man: Your 311 Illegal Parking Complaints Are 'Wasting Our Time' Streetsblog |
 "NYPD" - Google News "NYPD" - Google News | 7h | |
|
|
|
| Police: Man made lewd comments to girl at Hialeah bus stop, followed her aboard -... |
| Police: Man made lewd comments to girl at Hialeah bus stop, followed her aboard WPLG Local 10 |
 "police" - Google News "police" - Google News | 8h | |
|
|
|
| Nessel clears East Lansing officers in shooting of man in Meijer parking lot - Lansing... |
| Nessel clears East Lansing officers in shooting of man in Meijer parking lot Lansing State Journal |
 "police" - Google News "police" - Google News | 8h | |
|
|
|
| Valley police agencies warn about online sextortion - Arizona's Family |
| Valley police agencies warn about online sextortion Arizona's Family |
 "police" - Google News "police" - Google News | 8h | |
|
|
|
| Woman last seen wandering from College Park apartment, police say - FOX 5 Atlanta |
| Woman last seen wandering from College Park apartment, police say FOX 5 Atlanta |
 "police" - Google News "police" - Google News | 8h | |
|
|
|
| Police: Tractor operator used drugs prior to fatal motorcycle crash - WCAX |
| Police: Tractor operator used drugs prior to fatal motorcycle crash WCAX |
 "police" - Google News "police" - Google News | 8h | |
|
|
|
| Adrian Police investigating arson at charity building - WTVG |
| Adrian Police investigating arson at charity building WTVG |
 "police" - Google News "police" - Google News | 8h | |
|
|
|
| Police: Hicksville man arrested in string of Nassau burglaries - News 12 Bronx |
| Police: Hicksville man arrested in string of Nassau burglaries News 12 Bronx |
 "police" - Google News "police" - Google News | 8h | |
|
|
|
| Hangry women try to attack Wendy's drive-thru employee: Solon Police Blotter - cleveland.com |
| Hangry women try to attack Wendy's drive-thru employee: Solon Police Blotter cleveland.com |
 "police" - Google News "police" - Google News | 8h | |
|
|
|
| VCU students speak out about 'suspicious man' as Richmond police make arrest - WRIC... |
| VCU students speak out about 'suspicious man' as Richmond police make arrest WRIC ABC 8News |
 "police" - Google News "police" - Google News | 8h | |
|
|
|
| Funeral homes refused to handle services for Uvalde gunman: coroner - Insider |
| Funeral homes refused to handle services for Uvalde gunman: coroner Insider |
 "Robb Elementary Uvalde" - Google News "Robb Elementary Uvalde" - Google News | 8h | |
|
|
|
| Thief snatches 7 train rider's cellphone at Roosevelt Avenue transit hub in Woodside:... |
| Thief snatches 7 train rider's cellphone at Roosevelt Avenue transit hub in Woodside: NYPD – QNS.com QNS.com |
 "NYPD" - Google News "NYPD" - Google News | 8h | |
|
|
|
| Chattanooga Police Department National Night Out Kicks Off Oct. 4 - The Chattanoogan |
| Chattanooga Police Department National Night Out Kicks Off Oct. 4 The Chattanoogan |
 "police" - Google News "police" - Google News | 8h | |
|
|
|
| Shooting suspect leads Flint police on chase, crashes into building - MLive.com |
| Shooting suspect leads Flint police on chase, crashes into building MLive.com |
 "police" - Google News "police" - Google News | 8h | |
|
|
|
| D.C. police investigating homicides in Southeast, Northwest Washington - The Washington... |
| D.C. police investigating homicides in Southeast, Northwest Washington The Washington Post |
 "police" - Google News "police" - Google News | 8h | |
|
|
|
| Trinity University police warn public about a string of catalytic converter thefts... |
| Trinity University police warn public about a string of catalytic converter thefts KSAT San Antonio |
 "police" - Google News "police" - Google News | 8h | |
|
|
|
| Camp Hill Police looking for man who created fraudulent bank account - ABC27 |
| Camp Hill Police looking for man who created fraudulent bank account ABC27 |
 "police" - Google News "police" - Google News | 8h | |
|
|
|
| Argyle Police Blotter - August 2022 - The Cross Timbers Gazette |
| Argyle Police Blotter - August 2022 The Cross Timbers Gazette |
 "police" - Google News "police" - Google News | 8h | |
|
|
|
| Man arrested for impersonating police officer in Fayetteville - WRAL News |
| Man arrested for impersonating police officer in Fayetteville WRAL News |
 "police" - Google News "police" - Google News | 8h | |
|
|
|
| Uvalde school officials, Texas law enforcement could be sued over shooting - The... |
| Uvalde school officials, Texas law enforcement could be sued over shooting The Texas Tribune |
 "Robb Elementary Uvalde" - Google News "Robb Elementary Uvalde" - Google News | 8h | |
|
|
|
| Police blotter: Security camera captures would-be burglars - Wednesday Journal |
| Police blotter: Security camera captures would-be burglars Wednesday Journal |
 "police" - Google News "police" - Google News | 9h | |
|
|
|
| Austin police close park areas near Lady Bird Lake for homicide case - Austin American-Statesman |
| Austin police close park areas near Lady Bird Lake for homicide case Austin American-Statesman |
 "police" - Google News "police" - Google News | 9h | |
|
|
|
| Adrian police searching for suspect in suspicious fire - WILX |
| Adrian police searching for suspect in suspicious fire WILX |
 "police" - Google News "police" - Google News | 9h | |
|
|
|
| Vermont State Police interview two Ludlow police officers in officer-involved shooting... |
| Vermont State Police interview two Ludlow police officers in officer-involved shooting investigation WCAX |
 "police" - Google News "police" - Google News | 9h | |
|
|
|
| MSP police identify baby, locate mother safe - ABC 6 News - kaaltv.com - KAAL |
| MSP police identify baby, locate mother safe - ABC 6 News - kaaltv.com KAAL |
 "police" - Google News "police" - Google News | 9h | |
|
|
|
| Police: 2 dead, 5 injured in rash of daytime shootings across Philadelphia - FOX... |
| Police: 2 dead, 5 injured in rash of daytime shootings across Philadelphia FOX 29 Philadelphia |
 "police" - Google News "police" - Google News | 9h | |
|
|
|
| Teen Gunned Down in South Side Alley, Chicago Police Say - NBC Chicago |
| Teen Gunned Down in South Side Alley, Chicago Police Say NBC Chicago |
 "police" - Google News "police" - Google News | 9h | |
|
|
|
| Neighbors, police react after 1 dead, 1 injured in shooting inside Johns Creek home,... |
| Neighbors, police react after 1 dead, 1 injured in shooting inside Johns Creek home, police say WSB... |
 "police" - Google News "police" - Google News | 9h | |
|
|
|
 | Rep. Marjorie Taylor Greene says she was 'swatted' last night |
| "Last night, I was swatted just after 1 am," the Georgia Republican Rep. Marjorie Taylor Greene wrote... |
 NY Post: NYPD Blotter NY Post: NYPD Blotter | 9h | |
|
|
|
 | Florida Gov. Ron DeSantis bans ESG 'agenda' from state pension investments |
| Florida's resolution directs state fund manages to prioritize "the highest return on investment." |
 NY Post: NYPD Blotter NY Post: NYPD Blotter | 9h | |
|
|
|
 | Video shows the moment woman is attacked by rabid fox |
| The shocking video first made the rounds on Facebook. |
 NY Post: NYPD Blotter NY Post: NYPD Blotter | 9h | |
|
|
|
 | Lala Kent shares intimate details from Scheana Shay, Brock Davies' wedding |
| Shay married Davies at a luxe resort in Cancun, Mexico, Tuesday in front of numerous "Vanderpump Rules"... |
 NY Post: NYPD Blotter NY Post: NYPD Blotter | 9h | |
|
|
|
 | Biden set to announce student loan forgiveness for millions of Americans |
| While President Biden's student loan plan is expected to limit debt forgiveness to those earning less... |
 NY Post: NYPD Blotter NY Post: NYPD Blotter | 9h | |
|
|
|
 | Shaq shamelessly flirts with 'lovely' Australian radio host Jackie O |
| Shaquille O'Neal is always going to shoot his shot. On Tuesday, the NBA legend appeared on "The Kyle... |
 NY Post: NYPD Blotter NY Post: NYPD Blotter | 9h | |
|
|
|
 | Joe Rogan slams Hollywood's anti-firearm stance: 'Promote guns more than any other... |
| "Isn't it f--king wild that Hollywood in general is very anti-gun, but they promote guns more than any... |
 NY Post: NYPD Blotter NY Post: NYPD Blotter | 9h | |
|
|
|
 | Woman sues psychiatrist for approving gender transition after just one meeting |
| After his first meeting with the teen, Dr. Patrick Toohey concluded that Jay Langadinos suffered from... |
 NY Post: NYPD Blotter NY Post: NYPD Blotter | 9h | |
|
|
|
 | New on Netflix September 2022 |
| See Blonde, Netflix's very first NC-17 title, if you dare this month. |
 NY Post: NYPD Blotter NY Post: NYPD Blotter | 9h | |
|
|
|
 | It's Virgo season! The zodiac's beauty, finance, fitness and more 2022 trends |
| Join celebrity astrologer Kyle Thomas and some of his favorite celebrity tastemakers as they discuss... |
 NY Post: NYPD Blotter NY Post: NYPD Blotter | 9h | |
|
|
|
 | 'House of the Dragon' Showrunner Fires Back at Fan Backlash to Controversial Birth... |
| He said the women though it could be "more" violent. |
 NY Post: NYPD Blotter NY Post: NYPD Blotter | 9h | |
|
|
|
 | Horatio Sanz accuser claims Jimmy Fallon, Lorne Michaels were 'enablers' in sex assault |
| "Saturday Night Live" star Horatio Sanz was accused last year by a woman who claimed he sexually assaulted... |
 NY Post: NYPD Blotter NY Post: NYPD Blotter | 9h | |
|
|
|
 | Scuba diver demonstrates how to prevent shark attack — on live shark |
| "When we're dealing with top predators like sharks, we also want to act like a predator," says Kayleigh... |
 NY Post: NYPD Blotter NY Post: NYPD Blotter | 9h | |
|
|
|
 | 'Selling the OC' on Netflix: Follow the Real Estate Agents on Instagram |
| The drama's about to travel from the OC to Instagram. |
 NY Post: NYPD Blotter NY Post: NYPD Blotter | 9h | |
|
|
|
 | Katie Thurston admits John Hersey dumped her: 'A blessing in disguise' |
| "I just really put all my eggs in one basket with this man," the former "Bachelorette" told Kaitlyn Bristowe.... |
 NY Post: NYPD Blotter NY Post: NYPD Blotter | 9h | |
|
|
|
 | Tour Championship predictions, picks: Rory McIlroy among two outright bets to win |
| Rory McIlroy is one of the best bets at the Tour Championship. |
 NY Post: NYPD Blotter NY Post: NYPD Blotter | 9h | |
|
|
|
 | Hillary Clinton Thrashed in Legal Quiz by Kim Kardashian, Loses 11-4 |
| Clinton is looking a little rusty alongside legal whiz Kardashian. |
 NY Post: NYPD Blotter NY Post: NYPD Blotter | 9h | |
|
|
|
 | Ex-Universal Orlando worker convicted of attempting to meet minor for sex |
| The man exchanged messages with an officer he believed to be a 15-year-old girl in February. |
 NY Post: NYPD Blotter NY Post: NYPD Blotter | 9h | |
|
|
|
 | Heated Astros-Twins benches-clearing incident takes bizarre twist |
| Things escalated quickly in a tense – and bizarre – scene during Tuesday night's game between the Astros... |
 NY Post: NYPD Blotter NY Post: NYPD Blotter | 9h | |
|
|
|
| Arizona's 8-Foot Rule for Filming Police Faces First Amendment Lawsuit |
| The American Civil Liberties Union of Arizona, representing 10 journalism organizations, has filed a... |
 The Crime Report The Crime Report | 9h | |
|
|
|
| Whistleblower Accuses Twitter of Ignoring Security Flaws |
| Peiter Zatko, who served as Twitter's security chief until he was fired early this year, has filed a... |
 The Crime Report The Crime Report | 9h | |
|
|
|
| IRS Responds to Social Media Threats, Misinformation with Security Review |
| The Internal Revenue Service (IRS) is reviewing safety and security measures in response to an "abundance"... |
 The Crime Report The Crime Report | 9h | |
|
|
|
| Dallas Cops Now Required to Wear Body Cameras at Off-Duty Jobs |
| Dallas police officials are now requiring officers to wear their body-worn cameras at all off-duty jobs... |
 The Crime Report The Crime Report | 9h | |
|
|
|
| Marlborough police log, Aug. 26 edition - Community Advocate |
| Marlborough police log, Aug. 26 edition Community Advocate |
 "police" - Google News "police" - Google News | 9h | |
|
|
|
| Miami Springs police seek hit-and-run driver who critically injured motorcyclist... |
| Miami Springs police seek hit-and-run driver who critically injured motorcyclist WPLG Local 10 |
 "police" - Google News "police" - Google News | 9h | |
|
|
|
| Adrian police searching for arson suspect in charity fire - WTOL |
| Adrian police searching for arson suspect in charity fire WTOL |
 "police" - Google News "police" - Google News | 9h | |
|
|
|
| Texas county accused of violating state defunding police law - KWTX |
| Texas county accused of violating state defunding police law KWTX |
 "police" - Google News "police" - Google News | 9h | |
|
|
|
| Former police officer charged in 2020 death of Moline Acres sergeant hit, killed... |
| Former police officer charged in 2020 death of Moline Acres sergeant hit, killed during police chase KMOV4 |
 "police" - Google News "police" - Google News | 9h | |
|
|
|
| Metro police team up with MNPS to encourage students to pursue career in law enforcement... |
| Metro police team up with MNPS to encourage students to pursue career in law enforcement News Channel... |
 "police" - Google News "police" - Google News | 9h | |
|
|
|
| Suspect in custody after 2 Miami-Dade police officers stabbed, 1 airlifted to Ryder... |
| Suspect in custody after 2 Miami-Dade police officers stabbed, 1 airlifted to Ryder Trauma WPLG Local... |
 "police" - Google News "police" - Google News | 9h | |
|
|
|
| NYPD investigating 'hate crime assault pattern' in Brooklyn Jewish neighborhood -... |
| NYPD investigating 'hate crime assault pattern' in Brooklyn Jewish neighborhood Fox News |
 "NYPD" - Google News "NYPD" - Google News | 9h | |
|
|
|
 | Young Adult Use of Marijuana, Hallucinogens at All-Time High: Study |
| Photo by Cannabis Culture via Flickr In 2021, 11 percent of young adults said they used marijuana daily,... |
 The Crime Report The Crime Report | 9h | |
|
|
|
| Improved Facial Recognition Software Attracts Revived Interest |
| California's ban on police use of facial recognition is set to expire on Jan. 1, 2023, meaning cops in... |
 The Crime Report The Crime Report | 9h | |
|
|
|
| Jury Convicts Two Men of Plotting to Kidnap Michigan Gov |
| Barry Croft and Adam Fox have been convicted of plotting to kidnap Michigan's Gov. Gretchen Whitmer,... |
 The Crime Report The Crime Report | 9h | |
|
|
|
| Seattle Tests New Method for Identifying Homeless |
| In Seattle, the King County Regional Homelessness Authority (KCRHA) is testing a new method of better... |
 The Crime Report The Crime Report | 9h | |
|
|
|
| El Paso DA Launches Dashboard for Public Access to Criminal Justice Data |
| In response to increased public demand for governmental transparency, El Paso resident now hav e access... |
 The Crime Report The Crime Report | 9h | |
|
|
|
| Brookfield police say charges pending against reckless ATV drivers - WKBN.com |
| Brookfield police say charges pending against reckless ATV drivers WKBN.com |
 "police" - Google News "police" - Google News | 10h | |
|
|
|
| ACLU sues over Arizona law limiting filming of police - Police News |
| ACLU sues over Arizona law limiting filming of police Police News |
 "police" - Google News "police" - Google News | 10h | |
|
|
|
| Philadelphia playground shooting: Police release new video of suspect chase that... |
| Philadelphia playground shooting: Police release new video of suspect chase that ends in crash FOX 29... |
 "police" - Google News "police" - Google News | 10h | |
|
|
|
| Central NY theater, more businesses burglarized; police release suspect photos -... |
| Central NY theater, more businesses burglarized; police release suspect photos syracuse.com |
 "police" - Google News "police" - Google News | 10h | |
|
|
|
| Petaluma daughter lives with mother's corpse for more than a year: police - KTVU... |
| Petaluma daughter lives with mother's corpse for more than a year: police KTVU FOX 2 San Francisco |
 "police" - Google News "police" - Google News | 10h | |
|
|
|
| Phoenix police seek woman who hit Circle K employee with brick - The Arizona Republic |
| Phoenix police seek woman who hit Circle K employee with brick The Arizona Republic |
 "police" - Google News "police" - Google News | 10h | |
|
|
|
| Off-duty cop critically injured in brutal mugging on Bronx street: NYPD - AMNY |
| Off-duty cop critically injured in brutal mugging on Bronx street: NYPD AMNY |
 "NYPD" - Google News "NYPD" - Google News | 10h | |
|
|
|
 | Despite Bans, Ghost Gun Parts Still Coming Off the Assembly Line |
| photo via Polymer80 Even as thousands of untraceable guns bearing the branding stamp of Polymer80, one... |
 The Crime Report The Crime Report | 10h | |
|
|
|
| California Targets Rising Hate Crimes |
| The California Department of Justice launched new programs in 2021 to try to better combat hate crimes... |
 The Crime Report The Crime Report | 10h | |
|
|
|
 | '90 Day Fiancé' star Yve's lawyer calls Mohamed the 'Amber Heard of immigrants' |
| The reality star's rep previously told Page Six that her client is looking forward to the next steps... |
 NY Post: NYPD Blotter NY Post: NYPD Blotter | 10h | |
|
|
|
 | Sammy Watkins doubles down on 'amazing' Aaron Rodgers in Patrick Mahomes comparison |
| Sammy Watkins has caught passes from Patrick Mahomes and Lamar Jackson, among others, throughout his... |
 NY Post: NYPD Blotter NY Post: NYPD Blotter | 10h | |
|
|
|
 | Finnish PM Sanna Marin defends work record, right to private life |
| An emotional Prime Minister Sanna Marin told a crowd in Finland on Wednesday that she never missed a... |
 NY Post: NYPD Blotter NY Post: NYPD Blotter | 10h | |
|
|
|
 | Best tennis equipment guide: Shop racquets, shoes, bags and more |
| You'll "love" these top tennis picks. |
 NY Post: NYPD Blotter NY Post: NYPD Blotter | 10h | |
|
|
|
 | Alcohol, storm played role in crash that killed two Indiana State football players |
| The report by a Vigo County sheriff's deputy also states that one of the two ISU students who survived... |
 NY Post: NYPD Blotter NY Post: NYPD Blotter | 10h | |
|
|
|
 | 'Sweeney Todd' revival starring Josh Groban headed to Broadway |
| A revival of the late Stephen Sondheim's musical "Sweeney Todd" starring singer Josh Groban was announced... |
 NY Post: NYPD Blotter NY Post: NYPD Blotter | 10h | |
|
|
|
 | Garcelle Beauvais' son Jax shares despicable messages from 'RHOBH' fans |
| "I'm a f--king 14 year old leave me alone please," the reality star's son wrote via Instagram, calling... |
 NY Post: NYPD Blotter NY Post: NYPD Blotter | 10h | |
|
|
|
 | 'House of the Dragon': What Is Going on With the Cuts on King Viserys's Body? |
| Is there a secret meaning to those gross wounds? |
 NY Post: NYPD Blotter NY Post: NYPD Blotter | 10h | |
|
|
|
 | Only a select few can spot the number hidden in this optical illusion |
| It's like algebra for the eyes: Viral brain teaser enthusiasts are straining their brains trying to decipher... |
 NY Post: NYPD Blotter NY Post: NYPD Blotter | 10h | |
|
|
|
 | 2022 fantasy football: Is Zero-RB a strategy worth employing this season? |
| Is Zero-RB a strategy worth employing this season? |
 NY Post: NYPD Blotter NY Post: NYPD Blotter | 10h | |
|
|
|
 | How Joe Douglas' work building up the roster could help the Jets' rivals |
| The Jets have improved their roster depth dramatically, but now that leaves them with some hard decisions... |
 NY Post: NYPD Blotter NY Post: NYPD Blotter | 10h | |
|
|
|
 | Len Dawson, Hall of Fame quarterback, dead at 87 |
| Dawson, who was recently put in hospice care, was elected into the Hall of Fame as both a player and... |
 NY Post: NYPD Blotter NY Post: NYPD Blotter | 10h | |
|
|
|
 | 'Southern Charm' Star Craig Conover Confirms That Naomie Olindo And Whitney Sudler-Smith's... |
| "It wasn't manufactured, it was a real thing. I don't think either would do something that crazy for... |
 NY Post: NYPD Blotter NY Post: NYPD Blotter | 10h | |
|
|
|
 | Who Is John McAfee? Netflix's 'Running with the Devil' Tells the True Story of a... |
| You won't believe it until you see it. |
 NY Post: NYPD Blotter NY Post: NYPD Blotter | 10h | |
|
|
|
 | Demetrious Johnson makes no excuses ahead of ONE Championship rematch |
| Demetrious Johnson, the former longtime UFC flyweight champion, will face ONE Championship 135-pound... |
 NY Post: NYPD Blotter NY Post: NYPD Blotter | 10h | |
|
|
|
 | Elon Musk posts cryptic Disney tweet after ex-hacker blows whistle on Twitter |
| The Tesla boss tweeted a photo of the Disney character Jiminy Cricket making a whistling gesture. |
 NY Post: NYPD Blotter NY Post: NYPD Blotter | 10h | |
|
|
|
 | The Joe Schoen bets that are starting to pay off for the Giants |
| Trends are emerging from the Giants preseason, and, so far, the returns have been proimising for the... |
 NY Post: NYPD Blotter NY Post: NYPD Blotter | 10h | |
|
|
|
 | Derek Carr is 'removing' himself from the Tom Brady 'motherf–ker' drama |
| Raiders quarterback Derek Carr was seemingly unfazed by Dana White's recent assertion that he helped... |
 NY Post: NYPD Blotter NY Post: NYPD Blotter | 10h | |
|
|
|
 | Giants vs. Tigers prediction: Bet on Logan Webb in this spot |
| Logan Webb will lead the Giants past the Tigers on Wednesday, Stitches predicts. |
 NY Post: NYPD Blotter NY Post: NYPD Blotter | 10h | |
|
|
|
| Headlines - Police Press Release - August 23, 2022 - Anne Arundel County |
| Headlines - Police Press Release - August 23, 2022 Anne Arundel County |
 "police" - Google News "police" - Google News | 10h | |
|
|
|
| LIVE: Police investigating homicide in Auditorium Shores park - KXAN.com |
| LIVE: Police investigating homicide in Auditorium Shores park KXAN.com |
 "police" - Google News "police" - Google News | 10h | |
|
|
|
| Northborough police log, Aug. 26 edition - Community Advocate |
| Northborough police log, Aug. 26 edition Community Advocate |
 "police" - Google News "police" - Google News | 10h | |
|
|
|
| DA says Wauwatosa police shooting of teen was justified, files lawsuit - Milwaukee... |
| DA says Wauwatosa police shooting of teen was justified, files lawsuit Milwaukee Journal Sentinel |
 "police" - Google News "police" - Google News | 10h | |
|
|
|
| Man shot at Phoenix bus stop; police investigating apparent string of shootings -... |
| Man shot at Phoenix bus stop; police investigating apparent string of shootings Arizona's Family |
 "police" - Google News "police" - Google News | 10h | |
|
|
|
| Third suspect arrested after shots fired at police - WREG NewsChannel 3 |
| Third suspect arrested after shots fired at police WREG NewsChannel 3 |
 "police" - Google News "police" - Google News | 10h | |
|
|
|
| Man shot several times, hits pole trying to flee area, police say - FOX 5 Atlanta |
| Man shot several times, hits pole trying to flee area, police say FOX 5 Atlanta |
 "police" - Google News "police" - Google News | 10h | |
|
|
|
| Police search for 31-year-old man accused of murdering an Akron mom last month -... |
| Police search for 31-year-old man accused of murdering an Akron mom last month Cleveland 19 News |
 "police" - Google News "police" - Google News | 10h | |
|
|
|
| Seattle police union warns pending retirements may delay action on high priority... |
| Seattle police union warns pending retirements may delay action on high priority calls MyNorthwest |
 "police" - Google News "police" - Google News | 10h | |
|
|
|
| Police: Effort to alert school about counselor's arrest was unsuccessful - WWBT |
| Police: Effort to alert school about counselor's arrest was unsuccessful WWBT |
 "police" - Google News "police" - Google News | 11h | |
|
|
|
| City attorney investigating why San Rafael police dropped off homeless man in San... |
| City attorney investigating why San Rafael police dropped off homeless man in San Francisco KTVU FOX... |
 "police" - Google News "police" - Google News | 11h | |
|
|
|
| Southborough police log, Aug. 26 edition - Community Advocate |
| Southborough police log, Aug. 26 edition Community Advocate |
 "police" - Google News "police" - Google News | 11h | |
|
|
|
| Police investigation closes section of N. Bailey in Amherst - WIVB.com - News 4 |
| Police investigation closes section of N. Bailey in Amherst WIVB.com - News 4 |
 "police" - Google News "police" - Google News | 11h | |
|
|
|
| Arrest made in fatal hit-and-run that killed Shelbyville Police officer - WDRB |
| Arrest made in fatal hit-and-run that killed Shelbyville Police officer WDRB |
 "police" - Google News "police" - Google News | 11h | |
|
|
|
| Police are investigating a fiery tractor trailer crash on I-91 - WCAX |
| Police are investigating a fiery tractor trailer crash on I-91 WCAX |
 "police" - Google News "police" - Google News | 11h | |
|
|
|
| Police looking at road rage as motive for NW Side shooting - KSAT San Antonio |
| Police looking at road rage as motive for NW Side shooting KSAT San Antonio |
 "police" - Google News "police" - Google News | 11h | |
|
|
|
| Coconut Water, Juice Bandit Sought for Bizarre Bodega Robbery: NYPD - NBC New York |
| Coconut Water, Juice Bandit Sought for Bizarre Bodega Robbery: NYPD NBC New York |
 "NYPD" - Google News "NYPD" - Google News | 11h | |
|
|
|
| Conroe nonprofit Love Heals Youth delivers therapy tools, 650 meals to Uvalde - Houston... |
| Conroe nonprofit Love Heals Youth delivers therapy tools, 650 meals to Uvalde Houston Chronicle |
 "Robb Elementary Uvalde" - Google News "Robb Elementary Uvalde" - Google News | 11h | |
|
|
|
| Police: Man didn't like smell of cigar he bought so he dumped gas in Detroit store,... |
| Police: Man didn't like smell of cigar he bought so he dumped gas in Detroit store, set it on fire WDIV... |
 "police" - Google News "police" - Google News | 11h | |
|
|
|
| Kalamazoo police arrest woman on weapons charges while investigating shooting - MLive.com |
| Kalamazoo police arrest woman on weapons charges while investigating shooting MLive.com |
 "police" - Google News "police" - Google News | 11h | |
|
|
|
| Police: Suspect pointed gun at victim with child present - WHBF - OurQuadCities.com |
| Police: Suspect pointed gun at victim with child present WHBF - OurQuadCities.com |
 "police" - Google News "police" - Google News | 11h | |
|
|
|
 | There's precedent for Kevin Durant and the Nets to figure this out |
| Kevin Durant has put aside his differences with the Nets for now, and if he follows the lead of another... |
 NY Post: NYPD Blotter NY Post: NYPD Blotter | 12h | |
|
|
|
 | John Boyega praises Disney's defense of 'Obi-Wan' star against racism |
| "Moses Ingram being protected makes me feel protected," he said. |
 NY Post: NYPD Blotter NY Post: NYPD Blotter | 12h | |
|
|
|
| Police investigating overnight fatal crash in South Minneapolis - KSTP |
| Police investigating overnight fatal crash in South Minneapolis KSTP |
 "police" - Google News "police" - Google News | 12h | |
|
|
|
| Woman arrested, charged in hit-and-run death of Shelbyville Police officer - WLKY... |
| Woman arrested, charged in hit-and-run death of Shelbyville Police officer WLKY Louisville |
 "police" - Google News "police" - Google News | 12h | |
|
|
|
| Burlington Police commissioners question access to body camera footage - WCAX |
| Burlington Police commissioners question access to body camera footage WCAX |
 "police" - Google News "police" - Google News | 12h | |
|
|
|
| Brookfield police issue warrant, vow to catch group of reckless ATV drivers - WFMJ |
| Brookfield police issue warrant, vow to catch group of reckless ATV drivers WFMJ |
 "police" - Google News "police" - Google News | 12h | |
|
|
|
| Off-duty officer in critical but stable condition after attack, police say - Spectrum... |
| Off-duty officer in critical but stable condition after attack, police say Spectrum News NY1 |
 "NYPD" - Google News "NYPD" - Google News | 12h | |
|
|
|
| Off-duty NYPD officer hospitalized with fractured skull after ambush in the Bronx... |
| Off-duty NYPD officer hospitalized with fractured skull after ambush in the Bronx News 12 Long Island |
 "NYPD" - Google News "NYPD" - Google News | 12h | |
|
|
|
| Uvalde school board to consider firing district police chief - WVVA |
| Uvalde school board to consider firing district police chief WVVA |
 "Robb Elementary Uvalde" - Google News "Robb Elementary Uvalde" - Google News | 12h | |
|
|
|
| A look at police officer shortages in Milwaukee County suburbs - Milwaukee Journal... |
| A look at police officer shortages in Milwaukee County suburbs Milwaukee Journal Sentinel |
 "police" - Google News "police" - Google News | 12h | |
|
|
|
| Police Search for Suspect After Man Fatally Stabbed in Neck Near Mag Mile - NBC Chicago |
| Police Search for Suspect After Man Fatally Stabbed in Neck Near Mag Mile NBC Chicago |
 "police" - Google News "police" - Google News | 12h | |
|
|
|
| With State Ban Set to Expire, Local Police Could Bring Back Facial Rec - Voice of... |
| With State Ban Set to Expire, Local Police Could Bring Back Facial Rec Voice of San Diego |
 "police" - Google News "police" - Google News | 12h | |
|
|
|
| Atlanta Police continue to search for 24-year-old woman missing nearly a month -... |
| Atlanta Police continue to search for 24-year-old woman missing nearly a month CBS 46 News |
 "police" - Google News "police" - Google News | 12h | |
|
|
|
| Police: Keawe Street in Hilo Again Open | Big Island Now - Big Island Now |
| Police: Keawe Street in Hilo Again Open | Big Island Now Big Island Now |
 "police" - Google News "police" - Google News | 12h | |
|
|
|
| Kansas City police begin death investigation after man found shot to death Tuesday... |
| Kansas City police begin death investigation after man found shot to death Tuesday night KSHB 41 Kansas... |
 "police" - Google News "police" - Google News | 12h | |
|
|
|
| State police investigating theft of $25K from Ky. sheriff's office evidence room... |
| State police investigating theft of $25K from Ky. sheriff's office evidence room WKYT |
 "police" - Google News "police" - Google News | 12h | |
|
|
|
| Brattleboro man claims he killed an attacker in self-defense; police probing origin... |
| Brattleboro man claims he killed an attacker in self-defense; police probing origin of gun vtdigger.org |
 "police" - Google News "police" - Google News | 12h | |
|
|
|
| Georgetown police release new video showing moments before deadly 2021 shooting -... |
| Georgetown police release new video showing moments before deadly 2021 shooting WKYT |
 "police" - Google News "police" - Google News | 12h | |
|
|
|
| Rochester family seeking justice after crash injured a Buffalo Police Officer and... |
| Rochester family seeking justice after crash injured a Buffalo Police Officer and their loved one who... |
 "police" - Google News "police" - Google News | 12h | |
|
|
|
| NYPD hunting for 5 suspects in bizarre Manhattan frying pan attack - FOX 5 New York |
| NYPD hunting for 5 suspects in bizarre Manhattan frying pan attack FOX 5 New York |
 "NYPD" - Google News "NYPD" - Google News | 12h | |
|
|
|
| Residents say police investigation in McMinnville is a shooting - KATU |
| Residents say police investigation in McMinnville is a shooting KATU |
 "police" - Google News "police" - Google News | 13h | |
|
|
|
| Mom, 72, dies after son sets her on fire, police say - KSLA |
| Mom, 72, dies after son sets her on fire, police say KSLA |
 "police" - Google News "police" - Google News | 13h | |
|
|
|
| Police Release Additional Information About Officer-Involved Shooting in Hilo | Big... |
| Police Release Additional Information About Officer-Involved Shooting in Hilo | Big Island Now Big Island... |
 "police" - Google News "police" - Google News | 13h | |
|
|
|
| Police staffing concerns in San Jose - KRON4 |
| Police staffing concerns in San Jose KRON4 |
 "police" - Google News "police" - Google News | 13h | |
|
|
|
| Bozeman police discover drugs in bus - NBC Montana |
| Bozeman police discover drugs in bus NBC Montana |
 "police" - Google News "police" - Google News | 13h | |
|
|
|
| Hillsborough High student arrested after bringing gun to school, Tampa police say... |
| Hillsborough High student arrested after bringing gun to school, Tampa police say FOX 13 Tampa |
 "police" - Google News "police" - Google News | 13h | |
|
|
|
| Off-Duty NYPD Officer Critically Hurt in Mugging - NBC New York |
| Off-Duty NYPD Officer Critically Hurt in Mugging NBC New York |
 "NYPD" - Google News "NYPD" - Google News | 13h | |
|
|
|
| NYPD: 13-year-old girl arrested in connection to death of Bronx taxi driver - News... |
| NYPD: 13-year-old girl arrested in connection to death of Bronx taxi driver News 12 New Jersey |
 "NYPD" - Google News "NYPD" - Google News | 13h | |
|
|
|
 | Usher insists he’s ‘the King of R&B’: ‘I do deserve that’ |
| "I've been working to the point where I do own that, and I do deserve that," he added. |
 NY Post: NYPD Blotter NY Post: NYPD Blotter | 13h | |
|
|
|
 | Rick Ross says he'll offer $10M to anyone who will fight Jake Paul |
| The rapper claimed people are "afraid" to face the YouTuber-turned-boxer in the ring. |
 NY Post: NYPD Blotter NY Post: NYPD Blotter | 13h | |
|
|
|
 | Trump celebrates 'ALL' endorsement wins in primary: 'Great candidates!' |
| He later added: "26 and 0 tonight, turning numerous tight races into big and easy wins. Overall for last... |
 NY Post: NYPD Blotter NY Post: NYPD Blotter | 13h | |
|
|
|
 | Comedian Dave Chappelle turns 49 |
| Iconic and prolific comedian Dave Chappelle turns 49. |
 NY Post: NYPD Blotter NY Post: NYPD Blotter | 13h | |
|
|
|
 | Kvitova gets engaged to coach in 'special place' at Wimbledon |
| "Happy news we wanted to share with you guys ... I said 'yes' in my special place," said Petra Kvitova,... |
 NY Post: NYPD Blotter NY Post: NYPD Blotter | 13h | |
|
|
|
| Uvalde school board to consider firing district police chief - WJXT News4JAX |
| Uvalde school board to consider firing district police chief WJXT News4JAX |
 "Robb Elementary Uvalde" - Google News "Robb Elementary Uvalde" - Google News | 13h | |
|
|
|
| Safety on South Street: Are Philly police officers doing their jobs? - On top of... |
| Safety on South Street: Are Philly police officers doing their jobs? - On top of Philly news Billy Penn |
 "police" - Google News "police" - Google News | 13h | |
|
|
|
| Charlotte-Mecklenburg Police investigating homicide at north Charlotte convenience... |
| Charlotte-Mecklenburg Police investigating homicide at north Charlotte convenience store WBTV |
 "police" - Google News "police" - Google News | 13h | |
|
|
|
| Police officer admits to conspiracy in Breonna Taylor's killing - Axios |
| Police officer admits to conspiracy in Breonna Taylor's killing Axios |
 "police" - Google News "police" - Google News | 13h | |
|
|
|
| Cary Police Department unveils colorful SUVs for school resource officers - WRAL... |
| Cary Police Department unveils colorful SUVs for school resource officers WRAL News |
 "police" - Google News "police" - Google News | 13h | |
|
|
|
| Mom, 72, dies after son sets her on fire, police say - Live 5 News WCSC |
| Mom, 72, dies after son sets her on fire, police say Live 5 News WCSC |
 "police" - Google News "police" - Google News | 13h | |
|
|
|
| Forensics lab will soon be independent from Austin Police Department - KXAN.com |
| Forensics lab will soon be independent from Austin Police Department KXAN.com |
 "police" - Google News "police" - Google News | 13h | |
|
|
|
| Kenosha police officer accused of sexual assault on duty - Milwaukee Journal Sentinel |
| Kenosha police officer accused of sexual assault on duty Milwaukee Journal Sentinel |
 "police" - Google News "police" - Google News | 13h | |
|
|
|
| Police urge people of Liverpool to turn in killer of nine-year-old girl - The Guardian |
| Police urge people of Liverpool to turn in killer of nine-year-old girl The Guardian |
 "police" - Google News "police" - Google News | 14h | |
|
|
|
| Man impersonates parent at Ohio school, planned to kidnap child, police say - cleveland.com |
| Man impersonates parent at Ohio school, planned to kidnap child, police say cleveland.com |
 "police" - Google News "police" - Google News | 14h | |
|
|
|
| Kalamazoo police officers rescue alligator - WOODTV.com |
| Kalamazoo police officers rescue alligator WOODTV.com |
 "police" - Google News "police" - Google News | 14h | |
|
|
|
| POLICE CAMERAS: Council discusses cameras in Alexandria area seeing a recent crime... |
| POLICE CAMERAS: Council discusses cameras in Alexandria area seeing a recent crime increase KSLA |
 "police" - Google News "police" - Google News | 14h | |
|
|
|
| Police investigate crash on North Side - WKBN.com |
| Police investigate crash on North Side WKBN.com |
 "police" - Google News "police" - Google News | 14h | |
|
|
|
| Police chiefs back N.J. prosecutor in squabble with cops over new rule - NJ.com |
| Police chiefs back N.J. prosecutor in squabble with cops over new rule NJ.com |
 "police" - Google News "police" - Google News | 14h | |
|
|
|
| NYPD: 13-year-old girl arrested in connection to death of Bronx taxi driver - News... |
| NYPD: 13-year-old girl arrested in connection to death of Bronx taxi driver News 12 Long Island |
 "NYPD" - Google News "NYPD" - Google News | 14h | |
|
|
|
| Police: Muskegon Heights officers shot at, no one hit - WOODTV.com |
| Police: Muskegon Heights officers shot at, no one hit WOODTV.com |
 "police" - Google News "police" - Google News | 14h | |
|
|
|
 | Texas university offers course on Taylor Swift's songwriting this fall |
| Swift's songs will now be read aloud alongside work by literary giants such as Chaucer, Shakespeare,... |
 NY Post: NYPD Blotter NY Post: NYPD Blotter | 15h | |
|
|
|
 | Defiant Ukraine marks Independence Day six months after invasion |
| Public gatherings are banned in the capital Kyiv and a curfew is in force in the front-line eastern city... |
 NY Post: NYPD Blotter NY Post: NYPD Blotter | 15h | |
|
|
|
 | Phillies' Bryce Harper belts two homers in minor-league rehab game |
| With two big swings, Bryce Harper looked primed to join the Phillies in a pennant race. |
 NY Post: NYPD Blotter NY Post: NYPD Blotter | 15h | |
|
|
|
 | Yankees' Giancarlo Stanton expected to return Thursday vs. A's |
| The expectation is Yankees slugger Giancarlo Stanton will be activated on Thursday to be the DH in the... |
 NY Post: NYPD Blotter NY Post: NYPD Blotter | 15h | |
|
|
|
 | Sean Connery's personal James Bond Aston Martin DB5 sells for $2.4M |
| The car had a pre-auction estimate of $1.4 to $1.8 million, but the winning bidder paid $2,425,000, which... |
 NY Post: NYPD Blotter NY Post: NYPD Blotter | 15h | |
|
|
|
 | Justin Verlander pulled after six no-hit innings in Astros' win over Twins |
| Astros ace Justin Verlander was totally fine leaving with a no-hitter intact after six innings against... |
 NY Post: NYPD Blotter NY Post: NYPD Blotter | 15h | |
|
|
|
| Liverpool shooting: Police given name in hunt for Olivia's killer - BBC |
| Liverpool shooting: Police given name in hunt for Olivia's killer BBC |
 "police" - Google News "police" - Google News | 15h | |
|
|
|
| Alameda woman drilled hole in fuel tank to siphon gas: police - KRON4 |
| Alameda woman drilled hole in fuel tank to siphon gas: police KRON4 |
 "police" - Google News "police" - Google News | 15h | |
|
|
|
| Listen In, Lubbock: Uvalde weighs on Texans' minds as school starts back - KTTZ |
| Listen In, Lubbock: Uvalde weighs on Texans' minds as school starts back KTTZ |
 "Robb Elementary Uvalde" - Google News "Robb Elementary Uvalde" - Google News | 15h | |
|
|
|
| Petaluma police find body of woman believed dead since 2021 - The Santa Rosa Press... |
| Petaluma police find body of woman believed dead since 2021 The Santa Rosa Press Democrat |
 "police" - Google News "police" - Google News | 15h | |
|
|
|
| Police investigating after Muskegon Heights officer shot at, with related 3-car crash... |
| Police investigating after Muskegon Heights officer shot at, with related 3-car crash MLive.com |
 "police" - Google News "police" - Google News | 15h | |
|
|
|
| Frequently broken law police are watching drivers closely for - KAIT |
| Frequently broken law police are watching drivers closely for KAIT |
 "police" - Google News "police" - Google News | 15h | |
|
|
|
| Pairing counselors with campus police to support students - Inside Higher Ed |
| Pairing counselors with campus police to support students Inside Higher Ed |
 "police" - Google News "police" - Google News | 16h | |
|
|
|
| MSP police identify baby, find mother safe - KSTP.com Eyewitness News - KSTP |
| MSP police identify baby, find mother safe - KSTP.com Eyewitness News KSTP |
 "police" - Google News "police" - Google News | 16h | |
|
|
|
| McMinnville police respond to a man with a gun at an assisted living complex ending... |
| McMinnville police respond to a man with a gun at an assisted living complex ending in a deadly shooting KGW.com |
 "police" - Google News "police" - Google News | 16h | |
|
|
|
| Mom, 72, dies after son sets her on fire, police say - KLTV |
| Mom, 72, dies after son sets her on fire, police say KLTV |
 "police" - Google News "police" - Google News | 16h | |
|
|
|
| Man shot by East Lansing police charged with 7 felonies - WILX |
| Man shot by East Lansing police charged with 7 felonies WILX |
 "police" - Google News "police" - Google News | 16h | |
|
|
|
| Police Search Activity in Connection with the Homicide Investigation in Northfield... |
| Police Search Activity in Connection with the Homicide Investigation in Northfield | News Releases |... |
 "police" - Google News "police" - Google News | 16h | |
|
|
|
 | Demi Lovato remembers using opiates at 13 after car accident |
| "[That] should have been a major red flag," Lovato said. |
 NY Post: NYPD Blotter NY Post: NYPD Blotter | 16h | |
|
|
|
 | Texas cops seize 10 bundles of pot following traffic stop turned car chase |
| 18-year-old Azael Pena, was arrested and booked for marijuana possession in Cameron County, Texas. |
 NY Post: NYPD Blotter NY Post: NYPD Blotter | 16h | |
|
|
|
 | Mets' Taijuan Walker hurt by Aaron Judge homer: 'got a little too quick' |
| Mets starter Taijuan Walker pitched four perfect innings Tuesday. The other wasn't so perfect. |
 NY Post: NYPD Blotter NY Post: NYPD Blotter | 16h | |
|
|
|
 | Dear Abby: I can't move on from my husband's seven-year infidelity |
| Dear Abby advises a woman who can't get over her husband's long-term affair, and counsels a woman not... |
 NY Post: NYPD Blotter NY Post: NYPD Blotter | 16h | |
|
|
|
 | Yankees' Aaron Boone not putting Aroldis Chapman back in key spots yet |
| One-time Yankees closer Aroldis Chapman went from turning a corner to stuck in reverse. |
 NY Post: NYPD Blotter NY Post: NYPD Blotter | 16h | |
|
|
|
| Back to school, with panic buttons: The post-Uvalde scramble - Escanaba Daily Press |
| Back to school, with panic buttons: The post-Uvalde scramble Escanaba Daily Press |
 "Robb Elementary Uvalde" - Google News "Robb Elementary Uvalde" - Google News | 16h | |
|
|
|
| Mom, 72, dies after son sets her on fire, police say - WDBJ |
| Mom, 72, dies after son sets her on fire, police say WDBJ |
 "police" - Google News "police" - Google News | 16h | |
|
|
|
| Woman well known to police back in jail on shoplifting charge - KFDX - Texomashomepage.com |
| Woman well known to police back in jail on shoplifting charge KFDX - Texomashomepage.com |
 "police" - Google News "police" - Google News | 16h | |
|
|
|
| Police chase ends on Marquette campus, driver arrested - FOX 6 Milwaukee |
| Police chase ends on Marquette campus, driver arrested FOX 6 Milwaukee |
 "police" - Google News "police" - Google News | 16h | |
|
|
|
| Pakistan's former PM Imran Khan investigated by police under anti-terror law - CNN |
| Pakistan's former PM Imran Khan investigated by police under anti-terror law CNN |
 "police" - Google News "police" - Google News | 16h | |
|
|
|
| SEATTLE POLICE STAFFING: 'Unprecedented separation numbers' continue, though Southwest... |
| SEATTLE POLICE STAFFING: 'Unprecedented separation numbers' continue, though Southwest Precinct rebounds... |
 "police" - Google News "police" - Google News | 16h | |
|
|
|
| Police searching for parents of baby found at MSP Airport - FOX 9 Minneapolis-St.... |
| Police searching for parents of baby found at MSP Airport FOX 9 Minneapolis-St. Paul |
 "police" - Google News "police" - Google News | 17h | |
|
|
|
| NAACP Backs Police Chief; Asks Full Disclosure Of Information On Officers Moved To... |
| NAACP Backs Police Chief; Asks Full Disclosure Of Information On Officers Moved To Desk Jobs The Chattanoogan |
 "police" - Google News "police" - Google News | 17h | |
|
|
|
| Warsaw police ask for public's help following automobile thefts - WNDU |
| Warsaw police ask for public's help following automobile thefts WNDU |
 "police" - Google News "police" - Google News | 17h | |
|
|
|
| Austin police lower minimum staffing requirement for 911 operators, resulting in... |
| Austin police lower minimum staffing requirement for 911 operators, resulting in longer hold, response... |
 "police" - Google News "police" - Google News | 17h | |
|
|
|
| Man charged after police chase in stolen SUV ends with crash in Detroit - FOX 2 Detroit |
| Man charged after police chase in stolen SUV ends with crash in Detroit FOX 2 Detroit |
 "police" - Google News "police" - Google News | 17h | |
|
|
|
| POLICE BLOTTER: Alcona County police respond to 92 complaints - Alpena News |
| POLICE BLOTTER: Alcona County police respond to 92 complaints Alpena News |
 "police" - Google News "police" - Google News | 17h | |
|
|
|
| Colombia's police will boost efforts to replace coca fields - The Associated Press... |
| Colombia's police will boost efforts to replace coca fields The Associated Press - en Español |
 "police" - Google News "police" - Google News | 17h | |
|
|
|
| Police: Passenger Dies After Impaired Driver Collides With Two Parked Cars In North... |
| Police: Passenger Dies After Impaired Driver Collides With Two Parked Cars In North Charlotte WCCB Charlotte |
 "police" - Google News "police" - Google News | 17h | |
|
|
|
 | Mets undone by questionable baserunning in loss to Yankees |
| In a game in which each run mattered, the Mets cost themselves on the base paths Tuesday night. |
 NY Post: NYPD Blotter NY Post: NYPD Blotter | 18h | |
|
|
|
 | Atlanta officers won't face charges in shooting death of Rayshard Brooks |
| Two white Atlanta police officers will not face charges after one shot and killed 27-year-old black man... |
 NY Post: NYPD Blotter NY Post: NYPD Blotter | 18h | |
|
|
|
 | 5-year-old immigrant girl who drowned trying to come to US wanted to help disabled... |
| "What she wanted, at her young age, was a better future for her little brother," Sofia's aunt, Rosa Garcia,... |
 NY Post: NYPD Blotter NY Post: NYPD Blotter | 18h | |
|
|
|
 | 4 relatives found dead in apparent murder-suicide in Massachusetts |
| All four individuals are believed to be related to each other, according to the Essex County District... |
 NY Post: NYPD Blotter NY Post: NYPD Blotter | 18h | |
|
|
|
 | State and feds investigating mystery illness killing dogs in Michigan |
| The unidentified virus causes acute gastrointestinal problems and generally kills young dogs within three... |
 NY Post: NYPD Blotter NY Post: NYPD Blotter | 18h | |
|
|
|
 | Mets' Pete Alonso in middle of everything — good and bad — in loss |
| It would have been a perfect ending if Pete Alonso had gotten one last at-bat with the game on the line.... |
 NY Post: NYPD Blotter NY Post: NYPD Blotter | 18h | |
|
|
|
 | Yankees finally seeing fruits of trade deadline moves |
| As late as the final week of the 1996 season, the Yankees were still trying to rescind or redo a trade... |
 NY Post: NYPD Blotter NY Post: NYPD Blotter | 18h | |
|
|
|
 | 13-year-old girl charged in fatal beating of NYC cabbie Kutin Gyimah |
| The teen, who was charged with gang assault and theft of services, became the fourth suspect busted in... |
 NY Post: NYPD Blotter NY Post: NYPD Blotter | 18h | |
|
|
|
| Police: Avoid area of SE Madison due to domestic disturbance; no immediate threat... |
| Police: Avoid area of SE Madison due to domestic disturbance; no immediate threat to neighborhood Channel3000.com... |
 "police" - Google News "police" - Google News | 18h | |
|
|
|
| Arlington police negotiate largest single-year pay raise in city history - WFAA.com |
| Arlington police negotiate largest single-year pay raise in city history WFAA.com |
 "police" - Google News "police" - Google News | 18h | |
|
|
|
| One seriously injured in shooting on State Street in New Haven: Police - WTNH.com |
| One seriously injured in shooting on State Street in New Haven: Police WTNH.com |
 "police" - Google News "police" - Google News | 18h | |
|
|
|
| Police dog sniffs out stolen cash to catch Wells Fargo robbery suspect hiding at... |
| Police dog sniffs out stolen cash to catch Wells Fargo robbery suspect hiding at nearby Chase Bank WPLG... |
 "police" - Google News "police" - Google News | 18h | |
|
|
|
| Emporia Police launch investigation at Emporia High School - WIBW |
| Emporia Police launch investigation at Emporia High School WIBW |
 "police" - Google News "police" - Google News | 18h | |
|
|
|
| Uvalde school police chief's fate could be decided at Wednesday school board meeting... |
| Uvalde school police chief's fate could be decided at Wednesday school board meeting CNN |
 "police" - Google News "police" - Google News | 18h | |
|
|
|
| Harvard Graduate Student Rodrigo Ventocilla Dies After Alleged Police Mistreatment... |
| Harvard Graduate Student Rodrigo Ventocilla Dies After Alleged Police Mistreatment in Indonesia | News Harvard... |
 "police" - Google News "police" - Google News | 18h | |
|
|
|
| Colombia's police will boost efforts to replace coca fields - ABC News |
| Colombia's police will boost efforts to replace coca fields ABC News |
 "police" - Google News "police" - Google News | 18h | |
|
|
|
| Downtown hit-and-run leaves moped rider seriously injured; police searching for driver... |
| Downtown hit-and-run leaves moped rider seriously injured; police searching for driver KTLA Los Angeles |
 "police" - Google News "police" - Google News | 18h | |
|
|
|
| Police investigate shooting death of man dropped off at hospital - FOX 5 San Diego |
| Police investigate shooting death of man dropped off at hospital FOX 5 San Diego |
 "police" - Google News "police" - Google News | 18h | |
|
|
|
| Police: 32-year-old man, woman arrested for having sex on amusement park ride - WWBT |
| Police: 32-year-old man, woman arrested for having sex on amusement park ride WWBT |
 "police" - Google News "police" - Google News | 18h | |
|
|
|
| NYPD: 13-year-old girl arrested in connection to death of Bronx taxi driver - News... |
| NYPD: 13-year-old girl arrested in connection to death of Bronx taxi driver News 12 Bronx |
 "NYPD" - Google News "NYPD" - Google News | 19h | |
|
|
|
| Man dies in hit-and-run bicycle collision in Manhattan: NYPD - PIX11 New York News |
| Man dies in hit-and-run bicycle collision in Manhattan: NYPD PIX11 New York News |
 "NYPD" - Google News "NYPD" - Google News | 19h | |
|
|
|
| Uvalde School Board to Consider Firing District Police Chief - U.S. News & World... |
| Uvalde School Board to Consider Firing District Police Chief U.S. News & World Report |
 "police" - Google News "police" - Google News | 19h | |
|
|
|
| RTD names Dr. Joel Fitzgerald Sr. as new police and emergency management chief -... |
| RTD names Dr. Joel Fitzgerald Sr. as new police and emergency management chief Denver 7 Colorado News |
 "police" - Google News "police" - Google News | 19h | |
|
|
|
 | Nick Langworthy defeats Carl Paladino in ugly upstate GOP House primary |
| Carl Paladino/Nick Langworthy emerged victorious Tuesday after an ugly Republican primary in the redrawn... |
 NY Post: NYPD Blotter NY Post: NYPD Blotter | 19h | |
|
|
|
 | Democrat Pat Ryan wins 'bellwether' House special vote in Hudson Valley |
| Democrat Pat Ryan has won a special election for an open congressional seat north of New York City that... |
 NY Post: NYPD Blotter NY Post: NYPD Blotter | 19h | |
|
|
|
 | Aaron Judge continues to be everything for Yankees |
| The MVP long ago decided, Aaron Judge is taking pennant-race matters into his own very large hands. |
 NY Post: NYPD Blotter NY Post: NYPD Blotter | 19h | |
|
|
|
 | Liberty's season ends with lopsided Game 3 loss to Sky |
| Candace Parker had 14 points, 13 rebounds and eight assists to lead the Chicago Sky over the Liberty... |
 NY Post: NYPD Blotter NY Post: NYPD Blotter | 19h | |
|
|
|
 | Oswaldo Cabrera's clutch hit, throw to plate help propel Yankees to win |
| On Tuesday, the Oswaldo Cabrera's arm, eye and bat showed up to help lift the Yankees to a 4-2 win over... |
 NY Post: NYPD Blotter NY Post: NYPD Blotter | 19h | |
|
|
|
 | Jennifer Lopez and Ben Affleck enjoy boat ride during Italian honeymoon |
| The couple jetted off to Italy for their second honeymoon after getting married a second time over the... |
 NY Post: NYPD Blotter NY Post: NYPD Blotter | 19h | |
|
|
|
 | New Yorkers are still waiting to see if Kathy Hochul is Cuomo 2.0 |
| The idea that Hochul will do big, bold things she lacks the courage to campaign on is fiction. Without... |
 NY Post: NYPD Blotter NY Post: NYPD Blotter | 19h | |
|
|
|
| Families leading the charge for permanent Robb Elementary memorial in Uvalde - KSAT... |
| Families leading the charge for permanent Robb Elementary memorial in Uvalde KSAT San Antonio |
 "Robb Elementary Uvalde" - Google News "Robb Elementary Uvalde" - Google News | 19h | |
|
|
|
| Let's Try to Be Understanding with Everyone Who Responded to Uvalde - Campus Safety... |
| Let's Try to Be Understanding with Everyone Who Responded to Uvalde Campus Safety Magazine |
 "Robb Elementary Uvalde" - Google News "Robb Elementary Uvalde" - Google News | 19h | |
|
|
|
| Lansing police arrest 5 juveniles in shooting near Clifford Park - WILX |
| Lansing police arrest 5 juveniles in shooting near Clifford Park WILX |
 "police" - Google News "police" - Google News | 19h | |
|
|
|
| Pleasant Hill police ask public's help in locating a missing 14-year-old - KTVU FOX... |
| Pleasant Hill police ask public's help in locating a missing 14-year-old KTVU FOX 2 San Francisco |
 "police" - Google News "police" - Google News | 19h | |
|
|
|
| Police: Nothing suspicious found in package - KELOLAND.com |
| Police: Nothing suspicious found in package KELOLAND.com |
 "police" - Google News "police" - Google News | 19h | |
|
|
|
| DC police arrest teenage suspect in mass shooting at Juneteenth festival - ABC News |
| DC police arrest teenage suspect in mass shooting at Juneteenth festival ABC News |
 "police" - Google News "police" - Google News | 19h | |
|
|
|
| Carlos Correa meets Uvalde shooting survivor Mayah Zamora - MLB.com |
| Carlos Correa meets Uvalde shooting survivor Mayah Zamora MLB.com |
 "Robb Elementary Uvalde" - Google News "Robb Elementary Uvalde" - Google News | 20h | |
|
|
|
| Police seeking vehicle in police pursuit in Kill Devil Hills - WAVY.com |
| Police seeking vehicle in police pursuit in Kill Devil Hills WAVY.com |
 "police" - Google News "police" - Google News | 20h | |
|
|
|
| Suspect who drew police fire at Lents auto shop indicted on 20 charges, including... |
| Suspect who drew police fire at Lents auto shop indicted on 20 charges, including attempted murder OregonLive |
 "police" - Google News "police" - Google News | 20h | |
|
|
|
| CRIME STOPPERS: Springfield police search for fugitive they say is known to be violent.... |
| CRIME STOPPERS: Springfield police search for fugitive they say is known to be violent. KY3 |
 "police" - Google News "police" - Google News | 20h | |
|
|
|
| Emails about Fairfax counselor with solicitation conviction never made it to school... |
| Emails about Fairfax counselor with solicitation conviction never made it to school system, police said The... |
 "police" - Google News "police" - Google News | 20h | |
|
|
|
| 'Just normal Fontana stuff': Police search for gunman who shot innocent bystander... |
| 'Just normal Fontana stuff': Police search for gunman who shot innocent bystander KTLA Los Angeles |
 "police" - Google News "police" - Google News | 20h | |
|
|
|
| Ulta Beauty robberies lead to 5 arrests, 4 injured police officers - The Santa Rosa... |
| Ulta Beauty robberies lead to 5 arrests, 4 injured police officers The Santa Rosa Press Democrat |
 "police" - Google News "police" - Google News | 20h | |
|
|
|
| Police investigating after teens found unresponsive at McNaughton Park - WNDU |
| Police investigating after teens found unresponsive at McNaughton Park WNDU |
 "police" - Google News "police" - Google News | 20h | |
|
|
|
| Tigard Police bust felon with gun and drugs, arrest another on outstanding warrant... |
| Tigard Police bust felon with gun and drugs, arrest another on outstanding warrant KATU |
 "police" - Google News "police" - Google News | 20h | |
|
|
|
| Antioch police searching for missing 14-year-old girl - KRON4 |
| Antioch police searching for missing 14-year-old girl KRON4 |
 "police" - Google News "police" - Google News | 20h | |
|
|
|
| Saint George's Police Chief submits resignation - WIBW |
| Saint George's Police Chief submits resignation WIBW |
 "police" - Google News "police" - Google News | 20h | |
|
|
|
| Austin police release footage in shooting of carjacking suspect - KVUE.com |
| Austin police release footage in shooting of carjacking suspect KVUE.com |
 "police" - Google News "police" - Google News | 20h | |
|
|
|
 | 'Third Branch of Public Safety' Thrives in Albuquerque |
| Photo via ACS website. One year into its implementation, the Albuquerque Community Safety (ACS) Department... |
 The Crime Report The Crime Report | 20h | |
|
|
|
| NYPD: 13-year-old girl arrested in connection to death of Bronx taxi driver - News... |
| NYPD: 13-year-old girl arrested in connection to death of Bronx taxi driver News 12 Connecticut |
 "NYPD" - Google News "NYPD" - Google News | 20h | |
|
|
|
| 2 Jewish men were sprayed with fire extinguishers in separate incidents, NYPD says... |
| 2 Jewish men were sprayed with fire extinguishers in separate incidents, NYPD says Rockdale Newton Citizen |
 "NYPD" - Google News "NYPD" - Google News | 20h | |
|
|
|
| Police Release Surveillance Video To Find Bushwick Shooter: NYPD - Patch |
| Police Release Surveillance Video To Find Bushwick Shooter: NYPD Patch |
 "NYPD" - Google News "NYPD" - Google News | 20h | |
|
|
|
| 4 officers hurt when NYPD patrol cars collide while responding to shooting call in... |
| 4 officers hurt when NYPD patrol cars collide while responding to shooting call in Brooklyn WABC-TV |
 "NYPD" - Google News "NYPD" - Google News | 20h | |
|
|
|
| Wrong order at Wendy's leads to shooting, Frisco police say - FOX 4 News Dallas-Fort... |
| Wrong order at Wendy's leads to shooting, Frisco police say FOX 4 News Dallas-Fort Worth |
 "police" - Google News "police" - Google News | 21h | |
|
|
|
| Hawaii Police Department announces its 4-legged 'secret weapon' is retiring - Hawaii... |
| Hawaii Police Department announces its 4-legged 'secret weapon' is retiring Hawaii News Now |
 "police" - Google News "police" - Google News | 21h | |
|
|
|
 | Yankees hang on to sweep Mets with tense Subway Series win |
| Maybe the Yankees have stopped the bleeding — and they have the Mets, in part, to thank. |
 NY Post: NYPD Blotter NY Post: NYPD Blotter | 21h | |
|
|
|
 | Socialist left swamps Democratic centrist challengers in NY state Senate primaries |
| The political left held its own despite a concerted effort by Mayor Eric Adams and allies to counter... |
 NY Post: NYPD Blotter NY Post: NYPD Blotter | 21h | |
|
|
|
 | Greg Abbott: Eric Adams is all talk when it comes to 'open' borders |
| Mayor Adams likes to pat himself on the back for welcoming migrants with open arms to his sanctuary city.... |
 NY Post: NYPD Blotter NY Post: NYPD Blotter | 21h | |
|
|
|
 | MLB odds: Why you should bet the Mariners to win World Series as long shot |
| The Mariners, who have faced decades of disappointment, might finally be in a position to make a run... |
 NY Post: NYPD Blotter NY Post: NYPD Blotter | 21h | |
|
|
|
 | 'Teen Mom' alum Jenelle Evans not returning to spinoff: reports |
| Evans' rep revealed she won't be signing a contract with MTV to appear on "Teen Mom: The Next Chapter"... |
 NY Post: NYPD Blotter NY Post: NYPD Blotter | 21h | |
|
|
|
 | Five Nets questions with Kevin Durant drama over — for now |
| Now that Kevin Durant has rescinded his trade request and that all-encompassing melodrama has been put... |
 NY Post: NYPD Blotter NY Post: NYPD Blotter | 21h | |
|
|
|
 | Rep. Sean Patrick Maloney easily beats lefty Alessandra Biaggi in NY-17 |
| Maloney was accused of deceptive fundraising practices by making it appear in a pitch to supporters that... |
 NY Post: NYPD Blotter NY Post: NYPD Blotter | 21h | |
|
|
|
 | Alexander Romanov, Noah Dobson may be Islanders' pairing of future |
| The players, both 22 and born just one day apart, could be playing together for a long time if things... |
 NY Post: NYPD Blotter NY Post: NYPD Blotter | 21h | |
|
|
|
 | Canadian health care worker drowns on Facebook livestream |
| A health care worker drowned in a pool during a Facebook livestream last week — to the horror of her... |
 NY Post: NYPD Blotter NY Post: NYPD Blotter | 21h | |
|
|
|
 | Val Demings tramples rivals for right to face Marco Rubio, chance to be first black... |
| "We did it, Florida! We won the primary, now it's time for us to #RetireRubio," Demings tweeted Tuesday... |
 NY Post: NYPD Blotter NY Post: NYPD Blotter | 21h | |
|
|
|
 | Julia Fox clarifies comment about kids needing to work instead of play |
| The 32-year-old actress reiterated that kids "need to learn skills" but that doesn't mean parents should... |
 NY Post: NYPD Blotter NY Post: NYPD Blotter | 21h | |
|
|
|
 | The NY Times' minority-bashing hit on 'the American dream' |
| The Times lists account after account of Republican politicians and immigrants explaining why they believe... |
 NY Post: NYPD Blotter NY Post: NYPD Blotter | 21h | |
|
|
|
 | What it will take for Mets and Yankees to meet in true Subway Series |
| The chance for both the Mets and Yankees is to make it a real Subway Series (the October kind) is perhaps... |
 NY Post: NYPD Blotter NY Post: NYPD Blotter | 21h | |
|
|
|
 | Kristin Cavallari: I got a breast lift after breastfeeding 3 children |
| While Cavallari has no problem with a breast lift, she has previously shared with Page Six that other... |
 NY Post: NYPD Blotter NY Post: NYPD Blotter | 21h | |
|
|
|
 | Rep. Jerry Nadler knocks off Carolyn Maloney in NY-12 battle of House Dems |
| New York's controversial redistricting process pitted the two longtime allies against one other, sparking... |
 NY Post: NYPD Blotter NY Post: NYPD Blotter | 21h | |
|
|
|
 | Little Leaguer unleashes epic bat flip at World Series |
| The Little League World Series is a flippin' good time. |
 NY Post: NYPD Blotter NY Post: NYPD Blotter | 21h | |
|
|
|
 | Ranking injured Yankees by importance as playoff reinforcements |
| This is how I would rank the currently IL-bound Yankees in order of importance. |
 NY Post: NYPD Blotter NY Post: NYPD Blotter | 21h | |
|
|
|
| Man shot by East Lansing police in Meijer parking lot faces multiple felony charges... |
| Man shot by East Lansing police in Meijer parking lot faces multiple felony charges Lansing State Journal |
 "police" - Google News "police" - Google News | 21h | |
|
|
|
| Police identify suspect in Jennings shooting - KPLC |
| Police identify suspect in Jennings shooting KPLC |
 "police" - Google News "police" - Google News | 21h | |
|
|
|
| 'They come out laughing hysterically': Beloit Police investigate movie theatre assaults... |
| 'They come out laughing hysterically': Beloit Police investigate movie theatre assaults WKOW |
 "police" - Google News "police" - Google News | 21h | |
|
|
|
| Tacoma police response for suicidal person in South Tacoma shuts down road for hours... |
| Tacoma police response for suicidal person in South Tacoma shuts down road for hours Tacoma News Tribune |
 "police" - Google News "police" - Google News | 21h | |
|
|
|
| Sacramento police searching for missing 12-year-old - KTXL FOX 40 Sacramento |
| Sacramento police searching for missing 12-year-old KTXL FOX 40 Sacramento |
 "police" - Google News "police" - Google News | 21h | |
|
|
|
| City of Erie Police Make Arrest in Shots Fired Incident - erienewsnow.com |
| City of Erie Police Make Arrest in Shots Fired Incident erienewsnow.com |
 "police" - Google News "police" - Google News | 21h | |
|
|
|
| Robb Elementary principal moves to new role at Uvalde CISD - KXAN.com |
| Robb Elementary principal moves to new role at Uvalde CISD KXAN.com |
 "Robb Elementary Uvalde" - Google News "Robb Elementary Uvalde" - Google News | 21h | |
|
|
|
 | Forget eating just crickets – scientist proposes recycling wind turbine blades into... |
| EAST LANSING, MI- First it was insects…now it's wind turbines. In a story worthy of the Babylon Bee,... |
 Law Enforcement Today Law Enforcement Today | 21h | |
|
|
|
 | Diplomat from United Nations accused of raping neighbor claims immunity, released... |
| New York, NY: A United Nations diplomat from South Sudan was arrested on allegations of raping one of... |
 Law Enforcement Today Law Enforcement Today | 21h | |
|
|
|
 | 'Military grade psy-op': Twitter whistleblower vindicates Musk, claims 90% of users... |
| SAN FRANCISCO, CA- When billionaire Elon Musk decided to pull out of his deal to buy Twitter, it should... |
 Law Enforcement Today Law Enforcement Today | 21h | |
|
|
|
| NYC crime: NYPD officer critically hurt after being attacked while jogging in the... |
| NYC crime: NYPD officer critically hurt after being attacked while jogging in the Bronx WABC-TV |
 "NYPD" - Google News "NYPD" - Google News | 21h | |
|
|
|
| Scooter-Riding Duo Sought for Three NYC Armed Robberies in 32 Minutes: NYPD - NBC... |
| Scooter-Riding Duo Sought for Three NYC Armed Robberies in 32 Minutes: NYPD NBC New York |
 "NYPD" - Google News "NYPD" - Google News | 21h | |
|
|
|
| Attempted Rape Suspect Charged After Strangulating Woman: NYPD - Patch |
| Attempted Rape Suspect Charged After Strangulating Woman: NYPD Patch |
 "NYPD" - Google News "NYPD" - Google News | 21h | |
|
|
|
| Mount Vernon police officer killed in crash identified - Fox 10 News |
| Mount Vernon police officer killed in crash identified Fox 10 News |
 "police" - Google News "police" - Google News | 22h | |
|
|
|
| Police seek N.J. bank robber who fled on motorcycle - NJ.com |
| Police seek N.J. bank robber who fled on motorcycle NJ.com |
 "police" - Google News "police" - Google News | 22h | |
|
|
|
| Levant man crashes into several cars in Bangor, police say - WABI |
| Levant man crashes into several cars in Bangor, police say WABI |
 "police" - Google News "police" - Google News | 22h | |
|
|
|
| Police: Uncertain if homicides were random or targeted - KELOLAND.com |
| Police: Uncertain if homicides were random or targeted KELOLAND.com |
 "police" - Google News "police" - Google News | 22h | |
|
|
|
| 15 months before Uvalde massacre, Police Chief Arredondo raised security issues with... |
| 15 months before Uvalde massacre, Police Chief Arredondo raised security issues with school board News/Talk/Sports... |
 "Robb Elementary Uvalde" - Google News "Robb Elementary Uvalde" - Google News | 22h | |
|
|
|
 | Far-left city council votes to give themselves a massive raise after defunding police... |
| AUSTIN, TX – Nearly two years after voting to significantly reduce the police department budget and eliminate... |
 Law Enforcement Today Law Enforcement Today | 22h | |
|
|
|
 | Convicted sex offender who lives in homeless shelter, was released on no bail after... |
| NEW YORK CITY, NY – According to a report from Fox News, the suspect in a brutal sucker-punch knockout... |
 Law Enforcement Today Law Enforcement Today | 22h | |
|
|
|
| Las Cruces police searching for missing teen girl - Las Cruces Sun-News |
| Las Cruces police searching for missing teen girl Las Cruces Sun-News |
 "police" - Google News "police" - Google News | 22h | |
|
|
|
| Wrong order at Wendy's leads to shooting, Frisco police say - FOX 29 Philadelphia |
| Wrong order at Wendy's leads to shooting, Frisco police say FOX 29 Philadelphia |
 "police" - Google News "police" - Google News | 22h | |
|
|
|
| Morristown police charge man in hit-and-run crash that killed baby - WVLT |
| Morristown police charge man in hit-and-run crash that killed baby WVLT |
 "police" - Google News "police" - Google News | 22h | |
|
|
|
| Police: Suspect in Oklahoma deputy shooting planned to kill - ABC News |
| Police: Suspect in Oklahoma deputy shooting planned to kill ABC News |
 "police" - Google News "police" - Google News | 22h | |
|
|
|
| Police Blotter: July 31-Aug 6, 2022 - City of Hayward (.gov) |
| Police Blotter: July 31-Aug 6, 2022 City of Hayward (.gov) |
 "police" - Google News "police" - Google News | 22h | |
|
|
|
 | Bicyclist sought by cops after NYC collision leaves pedestrian dead |
| Gavin Lee, 44, was crossing 8th Avenue on West 22nd Street in Chelsea when he was hit by a male bicyclist... |
 NY Post: NYPD Blotter NY Post: NYPD Blotter | 22h | |
|
|
|
 | Florida Democrats choose Rep. Crist to challenge DeSantis |
| Crist's moderate stances could appeal to voters in Florida's teeming suburbs as Democrats seek to reverse... |
 NY Post: NYPD Blotter NY Post: NYPD Blotter | 22h | |
|
|
|
 | Anne Heche's son reveals significance of actress' final resting place |
| "We are convinced our Mom would love the site we have chosen for her; it's beautiful, serene and she... |
 NY Post: NYPD Blotter NY Post: NYPD Blotter | 22h | |
|
|
|
 | Paul Newman's kids sue foundation, claim dad's legacy is 'under assault' |
| Elinor "Nell' Newman and Susan Newman are suing Newman's Own Foundation for breach of fiduciary duty. |
 NY Post: NYPD Blotter NY Post: NYPD Blotter | 22h | |
|
|
|
 | Mets' Pete Alonso snaps his bat after Subway Series strikeout vs. Yankees |
| The Subway Series pressure may be getting to a slumping Pete Alonso. |
 NY Post: NYPD Blotter NY Post: NYPD Blotter | 22h | |
|
|
|
 | 'Celebrity Jeopardy!' cast revealed: Which A-listers made the cut |
| The next generation of "Jeopardy!" is here. |
 NY Post: NYPD Blotter NY Post: NYPD Blotter | 22h | |
|
|
|
 | Mets' Jacob deGrom will get ball to start series versus Rockies |
| Jacob deGrom will lead off against the Rockies. |
 NY Post: NYPD Blotter NY Post: NYPD Blotter | 22h | |
|
|
|
 | Lawyer asks jury to award Vanessa Bryant $40 million over Kobe crash photo |
| A lawyer for a family member of one of the seven victims killed in a helicopter crash that claimed the... |
 NY Post: NYPD Blotter NY Post: NYPD Blotter | 22h | |
|
|
|
 | Sterling Shepard avoids PUP list as Giants trim five from roster |
| A move the Giants did not make on Tuesday could be the most significant of any of their transactions... |
 NY Post: NYPD Blotter NY Post: NYPD Blotter | 22h | |
|
|
|
 | Cuba, Mexico report deaths in monkeypox-positive patients |
| One man died in Cuba and another in Mexico after testing positive for monkeypox, the countries announced. |
 NY Post: NYPD Blotter NY Post: NYPD Blotter | 22h | |
|
|
|
 | Aaron Judge belts 48th home run in Yankees-Mets Subway Series battle |
| Aaron Judge blasted a solo shot of Taijuan Walker in the fourth inning to give the Yankees a 1-0 lead... |
 NY Post: NYPD Blotter NY Post: NYPD Blotter | 22h | |
|
|
|
 | Kel Mitchell calls Jennette McCurdy 'courageous' for memoir revelations |
| "I remember what she went through when her mom passed," Mitchell tells Page Six of his former "Sam &... |
 NY Post: NYPD Blotter NY Post: NYPD Blotter | 22h | |
|
|
|
 | British scientists behind crucial COVID trial pivot to monkeypox treatment research |
| The British scientists behind one of the major therapeutic COVID-19 trials have turned their focus to... |
 NY Post: NYPD Blotter NY Post: NYPD Blotter | 22h | |
|
|
|
 | Inside Daniel Jones' progress learning Brian Daboll's new Giants offense |
| How the Giants want Jones to be does not always sync with what fans of the team want their quarterback... |
 NY Post: NYPD Blotter NY Post: NYPD Blotter | 22h | |
|
|
|
 | Gerrit Cole, Jameson Taillon thrilled to see Jordan Montgomery's success |
| After the Yankees had finished off a win over the Mets on Monday night, two of the television screens... |
 NY Post: NYPD Blotter NY Post: NYPD Blotter | 22h | |
|
|
|
 | Pedro Martinez has 'hard time' seeing Jacob deGrom leaving Mets after opt out |
| Martinez's admiration for the two-time Cy Young award winner deGrom runs deep. |
 NY Post: NYPD Blotter NY Post: NYPD Blotter | 22h | |
|
|
|
 | Ben Affleck caught staring at Jennifer Lopez wedding pics on Italian honeymoon |
| The actor appeared to be appreciating one photo in particular — the one of his blushing bride on a swing... |
 NY Post: NYPD Blotter NY Post: NYPD Blotter | 22h | |
|
|
|
 | Petra Khashoggi, lovechild of disgraced Brit pol Jonathan Aitken, elopes |
| Page Six has learned plastic surgery scion Danny Baker Jr. and Khashoggi, the secret daughter of the... |
 NY Post: NYPD Blotter NY Post: NYPD Blotter | 22h | |
|
|
|
| 15 months before Uvalde massacre, Police Chief Arredondo raised security issues with... |
| 15 months before Uvalde massacre, Police Chief Arredondo raised security issues with school board 1430wcmy.com |
 "Robb Elementary Uvalde" - Google News "Robb Elementary Uvalde" - Google News | 22h | |
|
|
|
| As Wallingford police prepare to vacate, current building continues to draw interest... |
| As Wallingford police prepare to vacate, current building continues to draw interest Meriden Record-Journal |
 "police" - Google News "police" - Google News | 23h | |
|
|
|
| Police: Ohio man pretended to be parent, planned to kidnap child at school event... |
| Police: Ohio man pretended to be parent, planned to kidnap child at school event 10TV |
 "police" - Google News "police" - Google News | 23h | |
|
|
|
| Council Bluffs Police: Shots fired in neighbors' dispute - WOWT |
| Council Bluffs Police: Shots fired in neighbors' dispute WOWT |
 "police" - Google News "police" - Google News | 23h | |
|
|
|
| Michigan State Police dashcam captures rollover crash on I-75 - WILX |
| Michigan State Police dashcam captures rollover crash on I-75 WILX |
 "police" - Google News "police" - Google News | 23h | |
|
|
|
| Police: Mother charged with leaving 4 small children in car - Action News 5 |
| Police: Mother charged with leaving 4 small children in car Action News 5 |
 "police" - Google News "police" - Google News | 23h | |
|
|
|
| Police chief: Dallas officers must wear body cameras during off-duty jobs - Police... |
| Police chief: Dallas officers must wear body cameras during off-duty jobs Police News |
 "police" - Google News "police" - Google News | 23h | |
|
|
|
| Report: Man charged with indecency tells police he needs girl - WKBN.com |
| Report: Man charged with indecency tells police he needs girl WKBN.com |
 "police" - Google News "police" - Google News | 23h | |
|
|
|
| Kenosha police officer fired, accused of sexually assaulting woman in custody - WDJT |
| Kenosha police officer fired, accused of sexually assaulting woman in custody WDJT |
 "police" - Google News "police" - Google News | 23h | |
|
|
|
| UPDATE: Police open Sioux Falls intersection, say 'suspicious package' not a threat... |
| UPDATE: Police open Sioux Falls intersection, say 'suspicious package' not a threat Dakota News Now |
 "police" - Google News "police" - Google News | 23h | |
|
|
|
| Chicago police officer with terminal cancer gets salute from FOP - WLS-TV |
| Chicago police officer with terminal cancer gets salute from FOP WLS-TV |
 "police" - Google News "police" - Google News | 23h | |
|
|
|
| Man dies after being shot at east Phoenix apartments, police say - FOX 10 News Phoenix |
| Man dies after being shot at east Phoenix apartments, police say FOX 10 News Phoenix |
 "police" - Google News "police" - Google News | 23h | |
|
|
|
| Off-duty NYPD cop critically injured in Bronx mugging - New York Post |
| Off-duty NYPD cop critically injured in Bronx mugging New York Post |
 "NYPD" - Google News "NYPD" - Google News | 23h | |
|
|
|
| 2 N.Y.P.D. Officers Placed on Desk Duty After Fatal Crash in Queens - The New York... |
| 2 N.Y.P.D. Officers Placed on Desk Duty After Fatal Crash in Queens The New York Times |
 "NYPD" - Google News "NYPD" - Google News | 23h | |
|
|
|
| Appeals court upholds D.C. law making it easier to discipline police - The Washington... |
| Appeals court upholds D.C. law making it easier to discipline police The Washington Post |
 "police" - Google News "police" - Google News | 23h | |
|
|
|
| Santa Barbara seeking public input on civilian police oversight system | News Channel... |
| Santa Barbara seeking public input on civilian police oversight system | News Channel 3-12 KEYT |
 "police" - Google News "police" - Google News | 23h | |
|
|
|
| New oversight plan means closer scrutiny of St. Louis Metropolitan Police Department... |
| New oversight plan means closer scrutiny of St. Louis Metropolitan Police Department KSDK.com |
 "police" - Google News "police" - Google News | 23h | |
|
|
|
| Sunrise Beach Police reminding drivers to slow down as school starts - KY3 |
| Sunrise Beach Police reminding drivers to slow down as school starts KY3 |
 "police" - Google News "police" - Google News | 23h | |
|
|
|
| Chatham Co. Police Chief addressing plans to enhance safety at Memorial Stadium -... |
| Chatham Co. Police Chief addressing plans to enhance safety at Memorial Stadium WTOC |
 "police" - Google News "police" - Google News | 23h | |
|
|
|
| Police: Suspect in Oklahoma deputy shooting planned to kill - The Associated Press... |
| Police: Suspect in Oklahoma deputy shooting planned to kill The Associated Press - en Español |
 "police" - Google News "police" - Google News | 23h | |
|
|
|
| Sioux Falls police arrest two in accidental shooting - KELOLAND.com |
| Sioux Falls police arrest two in accidental shooting KELOLAND.com |
 "police" - Google News "police" - Google News | 23h | |
|
|
|
| Police investigating road rage shooting on I-24 - WSMV 4 |
| Police investigating road rage shooting on I-24 WSMV 4 |
 "police" - Google News "police" - Google News | 23h | |
|
|
|
| Alabama Town Dissolves Police Department to Fire Two Cops - Reason |
| Alabama Town Dissolves Police Department to Fire Two Cops Reason |
 "police" - Google News "police" - Google News | 23h | |
|
|
|
| Lubbock Police identify victim in fatal Monday night shooting - KCBD |
| Lubbock Police identify victim in fatal Monday night shooting KCBD |
 "police" - Google News "police" - Google News | 23h | |
|
|
|
| S.C. police chiefs, governor hail sweeping police reforms in new law - Police News |
| S.C. police chiefs, governor hail sweeping police reforms in new law Police News |
 "police" - Google News "police" - Google News | 23h | |
|
|
|
| RTD has appointed a new chief of police, and wow, does he have a big job - Denverite |
| RTD has appointed a new chief of police, and wow, does he have a big job Denverite |
 "police" - Google News "police" - Google News | 23h | |
|
|
|
 | $5K Worth Of Liquor, Computer Stolen From Rosie Pizza Bar, NYPD Says - Patch |
| $5K Worth Of Liquor, Computer Stolen From Rosie Pizza Bar, NYPD Says Patch |
 "NYPD" - Google News "NYPD" - Google News | 23h | |
|
|
|
| Lebanon police car hit by driver near fairgrounds - WSMV 4 |
| Lebanon police car hit by driver near fairgrounds WSMV 4 |
 "police" - Google News "police" - Google News | 1d | |
|
|
|
| Coroner: Woman Dies After She Is Shot by Biloxi Police - U.S. News & World Report |
| Coroner: Woman Dies After She Is Shot by Biloxi Police U.S. News & World Report |
 "police" - Google News "police" - Google News | 1d | |
|
|
|
| UK to Remove Police Registration Requirement, Reinstates Overseas Priority Processing... |
| UK to Remove Police Registration Requirement, Reinstates Overseas Priority Processing Services JD Supra |
 "police" - Google News "police" - Google News | 1d | |
|
|
|
| San Rafael Police Officer Seen Dropping Off Homeless, Mentally Ill Man In San Francisco... |
| San Rafael Police Officer Seen Dropping Off Homeless, Mentally Ill Man In San Francisco SFist |
 "police" - Google News "police" - Google News | 1d | |
|
|
|
| Police are investigating the death of Vidalia school employee - Mississippi's Best... |
| Police are investigating the death of Vidalia school employee - Mississippi's Best Community Newspaper... |
 "police" - Google News "police" - Google News | 1d | |
|
|
|
| Massage therapist accused of inappropriately touching woman at spa, police say -... |
| Massage therapist accused of inappropriately touching woman at spa, police say Arizona's Family |
 "police" - Google News "police" - Google News | 1d | |
|
|
|
| Man arrested after multi-hour standoff with police in Eaton County - MLive.com |
| Man arrested after multi-hour standoff with police in Eaton County MLive.com |
 "police" - Google News "police" - Google News | 1d | |
|
|
|
| Miami duo stole more than a dozen catalytic converters, police say - WPLG Local 10 |
| Miami duo stole more than a dozen catalytic converters, police say WPLG Local 10 |
 "police" - Google News "police" - Google News | 1d | |
Comments
Post a Comment